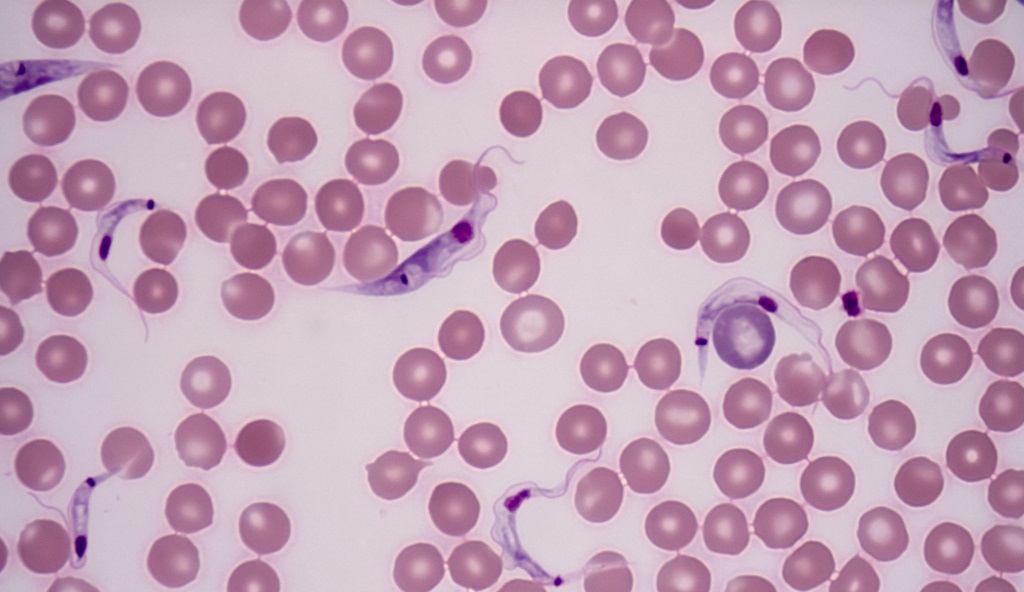

[sommaire]
Avant-propos
En cette année 2008, l’explosion des prix des denrées alimentaires sur le marché mondial vient aggraver considérablement l’insécurité alimentaire qui condamne déjà des millions de personnes sur la planète. De plus, en Asie, un cyclone vient de ravager une partie des récoltes de riz, dont dépend la survie de plusieurs millions d’africains et de latino-américains vivant dans l’extrême pauvreté.
Quand la faim et la disette frappent à la porte, et que les infrastructures élémentaires (eau, énergie, transport) pour assainir les lieux de vie ne sont pas présentes, le risque épidémiologique grandit.
Pour inspirer tout ceux et toutes celles engagés dans le combat pour la vie, nous avons décidé de présenter ici une partie d’un dossier spécial publié par la revue FUSION en 1988 sur « La grande aventure des Pasteuriens en Afrique et en Indochine », suivi du « Projet d’action épidémiologique », proposé à la même époque par l’économiste américain Lyndon LaRouche et la Commission médicale de la Fondation pour l’énergie de fusion (FEF).
Car une des leçons que l’on peut tirer du courage de ces jeunes pasteuriens, c’est que garantir la santé d’une population ne se réduit pas à « soigner les malades » mais que seule une « action en amont » permet de faire reculer la maladie.
Ayant parfois perdu toute vision d’un homme capable de produire des richesses, les « bonnes âmes » qui soulagent leur conscience en versant quelques euros pour la bonne cause, tendent malheureusement à oublier que sans une vraie politique de grands travaux en faveur d’infrastructures de base (eau, énergie, transports, etc.), tout l’argent du monde ne donnera pas la santé à ceux qui souffrent. En effet, sans eau, le lait en poudre risque d’être utilisé pour la construction de routes ; sans électricité le frigidaire du dispensaire sera incapable d’accueillir les vaccins, et sans eau de javel, les bactéries se répandront, y compris dans les lieux de soins.
C’est l’économie qui demeure la science de faire le bien à autrui, et l’économie est avant tout économie politique, un choix des hommes pour les hommes.
Si nous publions ce dossier, ce n’est donc pas pour contempler un passé courageux, mais pour arracher d’autres victoires demain.
L’imposante figure de Louis Pasteur
A l’origine des sciences de la vie, la biologie et la médecine, on trouve une figure imposante, Louis Pasteur. Et pourtant, même lors du centième anniversaire de l’Institut qui porte son nom, ses découvertes et sa contribution immense à l’humanité sont diminués. On se souvient de Pasteur pour son vaccin contre la rage ou pour la « pasteurisation » du lait, mais ce qui est essentiel, ce sans quoi il ne peut y avoir de vraie science, sa méthode et sa moralité active, est perdu.
Où est la preuve, où est l’expérience cruciale qui prouve que Pasteur avait raison, qu’il a toujours raison dans sa méthode ? Quelle est l’importance de sa méthode et de son idéal intérieur aujourd’hui ? Les réponses peuvent se trouver simplement dans une belle histoire, une histoire dans laquelle les découvertes les plus incroyables se succèdent, une histoire qui renferme plus de merveilles, qui est plus émouvante que n’importe quel conte de fée : l’histoire de l’engagement des pasteuriens en Afrique et en Asie.
La vérité est plus riche et plus belle que toutes les fables. - (Emile Roux)
La vision morale et les qualités d’entrepreneur de Pasteur sont presque oubliées. Cependant, Pasteur fut un économiste avant tout parce qu’il comprenait les phénomènes gouvernant la vie et qu’à ce titre, c’était un bâtisseur de nations.
Pendant la seconde moitié du dix-neuvième siècle, la France entreprend la colonisation de l’Afrique du Nord, du Centre et de l’Ouest, ainsi que celle de l’Indochine. Au même moment, de grands projets de développement sont entrepris par Ferdinand de Lesseps (citons le canal de Suez, conçu et terminé sur une période de vingt ans et le début du canal de Panama) et par Gustave Eiffel : à côté de la fameuse tour Eiffel et de la statue de la Liberté (la structure métallique est de lui), Eiffel a construit des ponts, des gares et des retenues d’eau dans le monde entier. Bref, c’est une période marquée par le mot favori de Pasteur : enthousiasme, un mot venant du grec et signifiant « Dieu intérieur » comme il le rappelait.
Albert Calmette, médecin de la « Royale », élève de Pasteur et fondateur du premier Institut Pasteur d’outre-mer à Saigon, déclarait :
Sans les découvertes de Pasteur, le développement et l’émancipation des populations indigènes, la mise en valeur de leur territoire, l’expansion colonisatrice de la France et des autres nations civilisées auraient été impossibles.
Pasteur promut un mouvement politique destiné à orienter la politique de l’administration coloniale et militaire française. L’idée était de parvenir à des niveaux de vie chez les colonisés tels qu’ils en viennent à souhaiter eux-mêmes être associés à la France. Aujourd’hui, s’il existe de bons souvenirs associés à la France en Afrique et en Asie, c’est grâce aux pasteuriens. Le Vietnam, par exemple, ravagé par la guerre, chérit encore la mémoire d’Alexandre Yersin. Il existe encore une douzaine d’Instituts Pasteur en dehors de la France : Tunisie, Algérie, Maroc, Sénégal, Mali, Madagascar, etc. Sans les pasteuriens, ces territoires étaient inaccessibles au développement à cause des épidémies et de l’infestation par les insectes. Seuls les rivages des mers étaient connus, tristes témoins du commerce d’esclaves. Les élèves de Pasteur cherchèrent à transformer ces régions, à révolutionner l’économie de ces pays ; ils combattirent sans relâche les politiques impériales de pillage auxquelles ils étaient opposés pour des raisons aussi bien morales que scientifiques.
Pour ces hommes, la santé, l’économie politique et la défense ne sont pas des domaines distincts et séparés, ils sont indissociables. Ce qui était en jeu pour les pasteuriens, c’était l’établissement d’une science du vivant, science de l’écologie et de l’économie d’une nation. La politique de santé en découle : la pensée d’une nation est réfléchie dans sa politique de santé ou dans le développement des individus qui la composent ou qui y sont associés. La santé est la relation de l’homme à la biosphère. Donc la santé consiste en :
- l’accroissement de la capacité de peuplement d’une région donnée ;
- l’accroissement de la qualité (bien-être, productivité et créativité des individus qui la composent).
Le mouvement pasteurien est l’antithèse du Club de Rome : ces hommes vont en Afrique ou en Asie pour accroître la population. La santé est définie comme l’établissement d’une relation harmonieuse entre le sol, l’hydrologie, les plantes, les animaux et l’homme, ainsi qu’une relation harmonieuse entre les micro-organismes et les macro-organismes.
Comme Charles Nicolle l’avait compris, si une politique de pillage prévalait, les épidémies traverseraient rapidement les mers et détruiraient les nations coupables d’idéaux impériaux. Seuls le médecin, le savant et l’instituteur ont le droit au titre de « colon », disait-il, seuls ceux qui sont prêts à donner, non à voler. L’immoralité de la politique d’après-guerre du FMI s’est moquée des avertissements de Nicolle et a détruit les principales réalisations pasteuriennes avec des conséquences dramatiques. En cette année qui marque le centième anniversaire de la création de l’Institut Pasteur, il est nécessaire de célébrer Pasteur et ses nombreux élèves mais il est aussi nécessaire de se rappeler cet effort de développement afin d’en reproduire l’esprit et la méthode indispensables pour sauver l’Afrique aujourd’hui.
De la levure aux microbes
Commençons par nous remettre en esprit succinctement la pensée de Pasteur sur l’étiologie des maladies infectieuses. Pasteur établit expérimentalement que des organismes vivants étaient la cause de la fermentation transformant le jus de raisin en vin. Etant donné que la fermentation ressemble à la dégradation des tissus malades, dit-il, les infections humaines et animales doivent également être dues à des micro-organismes se développant au détriment de leur hôte pour le transformer.
Il conclut que son travail sur les grappes de raisin établissait les principes à partir desquels on pouvait parvenir à la maîtrise et au traitement de toutes les maladies contagieuses. Il devait y avoir des micro-organismes différents à l’origine de chaque maladie individuelle ; la dissémination de ce micro-organisme rendait compte de la transmissibilité de la maladie d’une personne à une autre.
En 1857, Pasteur prouve expérimentalement que la fermentation alcoolique est « corrélative de la présence et la multiplication d’êtres organisés, distincts pour chaque fermentation ». Ces ferments ne sont pas « des matières albuminoïdes mortes, mais bien des êtres vivants, (...) la levure vient de l’extérieur, non de l’intérieur des grains ». Il montre que la levure a des propriétés optiques caractéristiques du vivant : elle effectue une rotation du plan de polarisation de la lumière, autrement dit, elle réalise une transformation de l’énergie, un travail.
En 1878, Pasteur redémontre de manière concluante, qu’il n’y a pas de fermentation s’il n’y a pas de levure sur les grains. Très vite, il va établir un parallèle entre la « maladie des grappes », la fermentation, et le processus de morbidité des maladies virulentes.
Le principe de la croissance ou de la régénérescence de l’organisme vivant, comme la capacité fascinante de cicatrisation, capacité des tissus à se régénérer eux-mêmes, qui est parallèle au comportement des cristaux, était à la base de la conceptualisation de la santé par Pasteur. Ici repose la maîtrise future des êtres vivants. Pour lui, cristallographe de pointe, le « devenir » du germe organique était similaire au « devenir » de la molécule chimique.
Rien de plus curieux que de pousser la comparaison des espèces vivantes et des espèces animales jusque dans les blessures aux unes et aux autres et des réparations de celles-ci par la nutrition, nutrition qui vient du dedans chez les êtres vivants et du dehors par le milieu de la cristallisation chez les autres.
La différence entre le « dedans » et le « dehors », ou la caractéristique de la vie doit être une force dissymétrique. La vie se replie sur elle-même à partir d’elle-même ; c’est le processus de « morbidité » et celui de cicatrisation qui fascinent Pasteur : le premier correspondrait à l’expansion de la vie des micro-organismes, le second à celle d’un organisme supérieur, les deux exprimant le principe de l’expansion autoréflexive.
Nicolle notait que tous les phénomènes du vivant peuvent être réduits à des processus physico-chimiques si nous coupons une « tranche instantanée », mais ce moment lui-même est mort, c’est dans « les séries de succession de ces moments » que l’on peut trouver le sens de la vie.
L’intuition de Pasteur est de situer la lumière comme principe organisant de la vie, vie qui est manifeste dans l’acte de rotation (voir ses commentaires sur la rotation vibrationnelle d’Est en Ouest) et dans sa nature dissymétrique. Sa pensée continue celle de Nicolas de Cues et de Leibniz ; comme eux, sa pensée scientifique et philosophique est totalement liée à son amour de l’humanité, d’où son engagement politique réel.
Il écrit donc à ses amis scientifiques et aux futurs dirigeants de son Institut qui sont disséminés dans différentes institutions :
Si seulement j’avais quelques millions, je vous dirais à tous, mes amis, Roux, Calmette, je vous dirais - Venez, nous allons transformer le monde avec nos découvertes.
Ainsi, en 1868, vingt ans avant la fondation du premier Institut à Paris, il entreprend de lancer le mouvement politique qui enverra ses élèves dans le monde entier :« Multipliez les laboratoires ! C’est là que l’humanité grandit, se fortifie et devient meilleure. »
Le mouvement pasteurien était né.
En 1876, il se présente aux élections sénatoriales dans sa région natale, refusant obstinément de traiter les petites questions localistes : « Avec moi c’est la science ; dans toute sa pureté, qui rentrera au Sénat. » Sa définition de la démocratie qui est redonnée dans un livre récent de Maurice Valléry-Radot vaut la peine d’être étudiée :
La vraie démocratie est celle qui permet à chaque individu de donner son maximum d’efforts dans le monde. ( ... ) Pourquoi faut-il qu’à côté de cette démocratie féconde, il en soit une autre, stérile et dangereuse qui, sous je ne sais quel prétexte d’égalité chimérique, rêve d’absorber et d’anéantir l’individu dans l’État. Cette fausse démocratie a le goût, j’oserais dire le culte de la médiocrité. Tout ce qui est supérieur lui est suspect. ( ... ) On pourrait définir cette démocratie : la ligue de tous ceux qui veulent vivre sans travailler, consommer sans produire, arriver aux emplois sans y être préparé, aux honneurs sans en être digne.
Pasteur était un politique dans le sens réel, scientifique, et trop souvent oublié du terme : il combattait contre l’usure, contre le mal, et pour que les hommes organisent leur économie comme la comprenaient un Monge ou un Carnot. Alors, la science économique était appelée polytechnique, autrement dit introduction d’inventions scientifiques pour améliorer la productivité de l’homme et sa maîtrise de l’environnement. Pour lui, la recherche scientifique est l’expression concrète de l’homme à l’image de Dieu : tout aimant.
Heureux celui qui porte en soi un Dieu intérieur, un idéal de beauté, et qui lui obéit : idéal de l’art, idéal de la science, idéal de la Patrie, idéal des vertus de l’Évangile. Ce sont là des sources vives des grandes pensées et des grandes actions. Toutes s’éclairent des reflets de l’infini.
Discours à l’Académie française du 27 Avril 1882
La notion « d’idéal intérieur » de Pasteur est la même que celle de « Beauté » de Schiller. L’élection sénatoriale, il la perdit, mais pour l’histoire, il a gagné.
Mission
Pasteur en 1870 :
Au point où nous sommes arrivés de ce qu’on appelle la civilisation moderne, la culture des sciences dans leur expression la plus élevée est peut-être plus nécessaire encore à l’état moral d’une nation qu’à sa prospérité matérielle.
A travers l’Afrique et l’Asie, les pasteuriens partirent en missions exploratoires, qui étaient des préludes à l’établissement de laboratoires et de stations expérimentales.
Dans la conquête d’un nouveau territoire, le premier pas est la « mission », comme Pasteur l’appelait. Ce terme signifie l’exploration de nouveaux territoires et la découverte de nouveaux peuples, non pour prendre ou visiter, mais pour apprendre, bâtir et apporter les bienfaits de la civilisation occidentale. On peut donner comme exemple la cartographie et l’étude de la prévalence de la maladie du sommeil en Afrique, laquelle exploration comprenait non seulement la cartographie de la maladie selon la manière dont elle pouvait affecter les villageois ou les différentes espèces d’animaux, mais aussi l’étude de la faune et de la flore régionales.
Par ces missions, les pasteuriens étaient capables de décider où et comment construire une route, quels étaient les problèmes d’agriculture et d’élevage que devaient affronter les villageois et comment la prophylaxie contre les principales épidémies devait être développée. Enfin, ils découvraient et étudiaient la vie des micro-organismes. Ils furent les premiers écologistes, si nous comprenons ce mot non dans son acceptation actuelle, anti-technologique, mais comme la compréhension et la maîtrise de l’économie des processus vivants.
L’histoire de la mission en Guinée du Docteur Martin, telle qu’elle est rapportée par son journal de bord, est typique des pionniers qui établirent les premiers Instituts Pasteur.
En juin et juillet de 1905, Martin accomplit une première mission exploratoire dans le Fouta Djallon, appelé les « Alpes suisses » de la Guinée à cause du terrain abrupt, des rivières torrentielles à traverser et des pics aigus de plus de 1500 m que l’on y rencontre. La mission parcourut 90 km à pied ou en porteur. Martin avait avec lui cinquante hommes, principalement des montagnards locaux, pour transporter l’équipement et la ménagerie d’animaux nécessaires aux expériences : moutons, chèvres, singes, chiens, chats, cochons d’Inde, perroquets, ainsi que deux génisses sur lesquelles la vaccine de Jenner était prélevée.
Le voyage fut excessivement dur : il n’est pour s’en convaincre que de citer quelques passages du journal de Martin.
« On se mettait en marche dès six heures du matin pour faire halte aux heures les plus chaudes, la température montant jusqu’à 35 degrés, chaleur chaude et humide. Par contre, la nuit, il faisait relativement froid et on avait besoin de s’envelopper de couvertures. ( ... ) Les repas étaient en général d’une extrême frugalité. On grappillait du maïs, on déjeunait d’une boîte de sardines et de pain sec ou moisi ou bien d’une soupe au lait et au tapioca. Les œufs achetés dans les villages indigènes étaient pourris dans la proportion de 3 sur 12. Parfois, on pouvait mettre la main sur un poulet étique que le cuisinier se mettait incontinent à plumer tout vivant, le tenant à la main, puis il le transportait ainsi pendant une dizaine de kilomètres sous un soleil ardent. La volaille était à moitié cuite lorsqu’on la mettait dans la casserole.
« Quand on arrivait à une étape pour y passer la nuit, on se mettait en quête d’une case dans laquelle il fallait se glisser à quatre pattes. Il régnait à l’intérieur une puanteur indéfinissable et on entendait les rats galoper sur la toiture en paille. Parfois lorsqu’on espérait pouvoir goûter un repos bien mérité après les fatigues de la journée, il fallait décamper devant l’envahissement de légions de grosses fourmis noires. D’autres fois c’était des nuées d’abeilles qui s’abattaient sur le campement, mettant la révolution parmi les animaux qui se dispersaient dans toutes les directions. ( ... )
« Les manipulations de laboratoire se faisaient en plein air. On montait une petite table sur laquelle on installait le microscope et l’on procédait aux examens de sang, aux autopsies d’animaux, à la récolte du vaccin. (…)
« Puis l’heure de la consultation médicale arrivait. Des villages voisins accouraient en un cortège lamentable, les malades chroniques : cachectiques paludéens, malades du sommeil en état de demi-somnolence, individus porteurs d’effroyables plaies éléphantiasiques, etc. »
Les sessions de vaccination attiraient beaucoup de monde lorsque les villageois en connaissaient déjà les bénéfices. Il est bon de rappeler les terribles effets de la variole avant l’arrivée des pasteuriens : plus de la moitié de la mortalité infantile lui était due ; dans certaines régions, plus de 90 % des jeunes adultes de 20 ans portaient les marques faciales indiquant qu’ils avaient survécu à cette terrible plaie.
Martin découvrit des trypanosomes dans les animaux domestiques les plus divers : équidés, ruminants, cochons ... Comme il voulait ramener ces micro-organismes en France, il dut retourner avec une ménagerie ambulante beaucoup plus grande que celle avec laquelle il était parti. En effet, les conditions de voyage précaires et le manque d’équipement pour le transport de cultures en milieu tropical faisaient que la manière la plus simple de ramener un échantillon d’une maladie était de ramener un ou plusieurs animaux infectés. Parfois, on emmenait un animal infecté et un non-infecté de façon à pouvoir transférer la maladie si le premier ne survivait pas au long voyage.
Martin découvrit également que la maladie du sommeil affectait tous les villages du fait de l’omniprésence de la glossina palpalis (espèce de mouche tsé-tsé) même aux plus hautes altitudes.
Plus tard, Martin entreprit des missions similaires au Congo et établit l’Institut Pasteur de Brazzaville. Parce que c’était la principale maladie du système nerveux affectant le continent, les pasteuriens décidèrent de lancer une guerre à la maladie du sommeil, une guerre que Jamot, dont nous parlerons plus loin, allait gagner un peu avant la deuxième guerre mondiale.
La grandeur et l’étendue de leurs découvertes scientifiques ne sont compréhensibles que si nous les voyons partagées entre la notion chrétienne de l’amour et ce dévouement infini à l’humanité qui est la seule musique des grands esprits.
Les pasteuriens prenaient des risques : beaucoup périrent en mission ou dans les territoires frappés par l’épidémie. Ils prirent des risques parce que, comme le disait un autre grand médecin du siècle, le chirurgien Merle d’Aubigné, sans un certain amour du risque, la vie perd beaucoup de ses charmes car alors l’homme cesse de penser.
Il existe un parallèle entre la rudesse physique avec laquelle les pasteuriens exploraient les territoires et les maladies dangereuses, et leur capacité à « prendre des risques » dans leurs réflexions mentales : cette capacité qui exige l’attitude courageuse de laisser derrière soi tout ce qu’on avait cru vrai auparavant pour explorer une nouvelle hypothèse et, en retour, comme Pasteur le disait souvent le courage de soumettre cette hypothèse au crible d’une expérimentation rigoureuse pour tenter de l’invalider, afin de déterminer si elle est valide, non-valide ou si elle doit être surpassée par une nouvelle hypothèse.
Mais comment passe-t-on de la mission à l’Institut ? Un exemple parmi tant d’autres est celui de Yersin dont nous allons résumer l’œuvre.
Yersin l’inventeur - De la peste à l’étude des étoiles
De la mission à l’Institut Pasteur, il n’y a qu’un pas ; il suffit pour cela d’explorer quelques contrées, d’étudier les maladies sévissant parmi les populations autochtones, leur bétail et les animaux sauvages, de maîtriser quelques agents de maladies, de trouver un remède et surtout une prévention efficace, c’est à dire un vaccin, et puis il faut établir quelque chose en dur, depuis la cabane jusqu’à la case, le laboratoire, la maison, puis les étables, et puis il faut encore trouver la main d’œuvre et les moyens financiers. En bref : il suffit d’être un scientifique accompli dans une douzaine de domaines, d’avoir une foi de fer, une capacité de travail herculéenne, et un courage hors du commun.
On serait en peine de trouver pareil être humain aujourd’hui en Europe, Mais la description convient bien aux disciples de Pasteur, et notamment à Alexandre Yersin, un homme tout à fait extraordinaire.
Jeune étudiant en médecine du canton de Vaud, en Suisse, Yersin (23 ans) est recruté par Roux (33 ans), dont on dit qu’il avait un œil d’aigle dans son choix de jeunes recrues étudiant en médecine pour démarrer un Institut Pasteur dirigé par deux chimistes : Pasteur et Duclaux.
Emile Roux, qui sera le second directeur de l’Institut Pasteur, passe aujourd’hui pour un homme au visage sévère, un ascète dont André Lwoff moque la pauvreté, Il avait cette richesse que donne la passion de l’art scientifique qui manque si évidemment à ses détracteurs.
Legroux, qui enseigna plus tard le « Grand Cours », dit de lui :
Il ne voulait pas faire de leçon à l’amphithéâtre mais dans le laboratoire des manipulations, groupant autour de lui ses auditeurs, expliquant devant le tableau noir la vie des infiniment petits, leur rôle aussi bien dans la maladie que dans la nature ; tous ceux qui ont entendu ces leçons sur le rôle des microbes à la surface du soi avaient l’impression de vivre dans un monde nouveau où tout se réglait suivant des lois que l’on pouvait faire varier, un monde où l’on devenait créateur après avoir été spectateur.
Pendant des années, Yersin va être le préparateur de Roux. Les deux jeunes gens s’attèlent à la résolution de la question de la diphtérie. Pourquoi la diphtérie ? Parce qu’il ne s’agit pas de faire un travail pour gagner des Prix et des Rubans, des Sous et des Positions, mais qu’il s’agit de sauver des millions d’enfants. Car les nouveau-nés sont particulièrement décimés par la diphtérie : fièvre, poussée de fausses membranes étouffant l’enfant, puis paralysie indiquant l’atteinte des centres nerveux, et enfin la mort, inéluctable. On a beau couper les membranes quand l’enfant étouffe, rien n’y fait.
Le bacille de la diphtérie avait été identifié outre-rhin par Klebs et Loeffler, mais, comme pour le HIV aujourd’hui, on ignorait le mécanisme par lequel le bacille tuait l’organisme infecté. Depuis longtemps, Roux pensait que la paralysie des muscles respiratoires indiquait la présence d’un poison ou d’une toxine sécrétée par le bacille.
Pour le prouver, Roux et Yersin vont injecter à des animaux un filtrat de culture de bacille (culture filtrée pour enlever les bacilles). Les animaux tombèrent malades prouvant la véracité de l’hypothèse. Cette découverte est suivie en retour d’une percée allemande par Von Bering qui découvre l’antitoxine produite par l’organisme affecté par la diphtérie.
Yersin et Roux ont alors une idée de génie qui marquera la deuxième révolution médicale après celle du « vaccin ». Ils injectent un bacille « atténué » (avec de l’iode) à des chevaux qui produiront alors des antitoxines dans leur sérum. Ce sérum agglutine les bacilles et neutralise les toxines. Il pouvait être utilisé comme moyen d’immuniser les enfants, ou de les guérir quand il était injecté assez tôt après l’infection.
Cette « petite » invention redonnera vie à la moitié des nouveau-nés car auparavant, un enfant sur deux mourait de cette maladie. C’est dire que nos aïeux durent leur existence à Roux et Yersin, et nous aussi. La sérothérapie était née qui allait être le principal traitement de toutes les maladies infectieuses, jusqu’à la venue des antibiotiques dans les années quarante. L’extraordinaire essor de la population mondiale au vingtième siècle est donc un cadeau de Pasteur et ses disciples.
Conquérir
Yersin, déjà célèbre à 25 ans, est alors chargé du Grand Cours de Microbiologie à l’Institut Pasteur, là où, du monde entier, les jeunes et moins jeunes scientifiques ou aspirants médecin viennent apprendre la nouvelle science des microbes. Il s’y trouve par décision de Roux, seul maître du Grand Cours auparavant.
Mais Yersin trouve les élèves « trop niais, trop nuls », l’enseignement « passif » n’est pas fait pour son esprit mouvementé. Alors, avec l’appui de Pasteur, il prend le large et démissionne de l’Institut Pasteur pour aller explorer l’Extrême-Orient qui l’attire. Il s’embarque comme simple médecin de bord sur les Messageries Maritimes qui font l’aller et retour vers Saigon. Pourquoi Pasteur l’appuie-t-il ? Parce qu’on ne tient pas un tel génie en laisse, ce serait contraire même à la philosophie de Pasteur pour qui Yersin est un miroir de son propre génie créateur, même si d’autres à l’Institut font la grimace.
Yersin revient d’ailleurs voir Pasteur pour lui conter ses aventures d’explorateur sur la côte indochinoise et lui proposer d’intercéder auprès du ministère des Colonies pour que lui soit octroyée la responsabilité de missions d’exploration, entre la côte d’Annam et le Mékong, après tout très utiles et même nécessaires à l’entreprise de conquête coloniale. Pasteur l’obtient, et Yersin abandonne les Messageries pour l’exploration.
Journal de bord, 16 mai 1892, vers le Haut Don Naï :
« L’orage est imminent. Je pars en avant avec un guide. Je porte avec moi mon chronomètre. Les chemins sont affreux. On trouve un immense marécage dans lequel on a le plus souvent de l’eau jusqu’à mi-corps. Il y a une quantité incroyable d’énormes sangsues. Grâce à mes vêtements, je suis à peu près épargné, mais mes pauvres Moïs ! Bientôt voilà la pluie qui commence, la nuit devient noire au point que, marchant à toucher mon guide, je ne le vois pas. Nous traversons je crois, une forêt, des rizières (où je perds mes chaussures dans la boue) et un bois de bambous. Enfin, nous entendons dans le lointain le tamtam et les gongs. Guidés par l’ouïe nous finissons par arriver... Heureusement le chronomètre n’a pas souffert dans cette course nocturne. »
Le chronomètre faisait que Yersin allait toujours à pied, pour ne pas déréglé l’instrument qui lui permettait, guidé par les étoiles et le soleil, de faire des cartes de ces pays Moï (sauvages, en annamite) où les Européens n’avaient jamais mis les pieds, et où les chemins étaient inexistants. Yersin conclut son exposé
« Riche région agricole au Sud, région d’élevage dans le centre, région aurifère vers le Nord : voilà les grandes productions du pays Moï. Je ne parle pas de l’ivoire que l’on trouve un peu partout et d’une multitude d’autres produits secondaires : cannelle, thé, tabac, essences diverses, cire, etc., qui pourront alimenter le commerce. Mais encore une fois commençons par organiser le pays qui deviendra, j’en suis persuadé’ prospère dès que l’anarchie et les guerres cesseront d’y régner en maîtres. »
« Colonialiste ! » crieront certains pour qui les Moïs auraient dû être abandonnés misérablement dans une nature moins que docile, une nature aussi belle que furibonde. Yersin fut un colonialiste, un colon qui travaillait pour que l’homme quelque fut son origine, puisse s’élever. Les horreurs du Vietnam survenues après, ont détruit son œuvre, méprisée par les extrémistes des deux bords.
Quelle fut cette œuvre ?
De passage à Saigon, Yersin y rencontre un ancien confrère de l’Institut Pasteur, Calmette, que Pasteur et le ministère des Colonies viennent d’envoyer pour y fonder le premier Institut Pasteur d’Outre-mer. Calmette fait partie du Corps de santé colonial que Pasteur vient de créer en s’alliant avec ce que la médecine militaire a de meilleur. Calmette recrute Yersin dans le Corps de santé colonial, en bref le réintègre dans les troupes de l’Institut. Comment ? En lui proposant une tâche aussi effarante que grandiose : aller, au milieu d’épidémies de peste bubonique, chercher la solution à cette maladie fulgurante et mystérieuse, dont presque personne ne réchappe.
Tristement célèbre depuis qu’elle avait fauché la moitié sinon plus de la population européenne au quatorzième siècle, réapparue brièvement pour décimer, entre autres, Marseille en 1720 (à cause d’une quarantaine non-respectée) elle restait périodiquement endémique en Asie. Voilà qu’elle réapparaissait, au beau milieu de l’extraordinaire essor des échanges commerciaux avec l’Asie sur la fin du dix-neuvième siècle. Elle décime Hong-Kong. Avec les nouveaux bateaux rapides, elle sera à Londres en quelques jours, quelques semaines. Les capitales européennes retiennent leur souffle. Et Yersin débarque à Hong-Kong, avec son microscope, seul refuge, seul dans la cité infestée.
A l’hôpital de Hong-Kong, Kitasato, le brillant élève de Koch, fait des autopsies avec l’accord des autorités britanniques. Yersin assiste à l’une d’entre elles et se demande pourquoi le bubon n’est pas examiné. Il tombe immédiatement sur l’idée qui avait échappé à Kitasato : l’agent de la maladie pourrait se trouver dans le bubon et non dans le sang. Comme on lui refuse des corps pour l’expérimentation, il dresse une tente sur la voie publique et soudoie quelques soldats pour lui permettre d’aller dans les charniers (100 000 personnes sont mortes ou mourantes alors) ramener quelques bubons.
Comme Yersin n’avait qu’un autoclave, il essaie, avec les moyens du bord, de cultiver le bacille en forme de long bâton qu’il voit au microscope, à une température (ambiante) de 27°, bien au-dessous des 37 ° habituels en microbiologie. Or le bacille proliférait justement en dessous de 30°. Kitasato, lui, qui cultive ce qu’il trouve dans le sang avec une étuve à 37°, ne cultive comme bacilles qu’un streptocoque, annoncé à tort comme responsable de la peste. Son intuition étant secondée ainsi par le hasard, Yersin fait l’expérience d’inoculer sa culture aux rats, inoculation qui leur communique la maladie. Il avait donc trouvé l’agent. Les associés de Kitasato reconnaîtront par la suite Yersin comme le premier découvreur du bacille. Yersin fait ensuite l’autopsie des rats morts trouvés dans les rues et découvre qu’ils étaient morts de la peste.
Il revint à l’Institut Pasteur avec ces deux découvertes importantes :
- l’agent de la peste,
- l’hypothèse que l’épidémie chez les rats précédait l’épidémie humaine.
Depuis les temps les plus reculés, la corrélation entre la peste des rats et la peste humaine était inconnue : les illustrations des premières bibles montrent des rats vivants sur la scène, indiquant que l’on ignorait que la population des rats aurait été décimée avant la peste humaine. Seul un antique poème indien, Bhâgavata Purana, dit :
Si tu vois un rat tomber du toit et errer dans la ville comme un homme ivre, sauve-toi car la peste est à portée de ta main.
Très vite, Roux à Paris et Yersin sur place se mettent à fabriquer un sérum contre la peste. Yersin, qui avait repéré le petit village de pêcheur nommé Nah Trang, s’y installe pour y rassembler les ressources et les chevaux nécessaires à la fabrication en masse de sérum.
A la demande pressante des autorités britanniques, Yersin va à Bombay avec 100 000 doses de sérum, pour y traiter une épidémie de peste, avec un autre pasteurien, Simond. Ce dernier identifie le mécanisme de transmission des rats aux hommes : les puces.
Désormais l’humanité connaît la source de la peste, le bacille « Yersini Pestii », et pourra se protéger par la dératisation des ports et des navires d’abord, puis, en partie, des villes, et par l’utilisation de désinfectants et d’insecticides contre les puces. Les cas isolés seront immédiatement traités au sérum.
Nah Trang
Extrait du Journal du Maréchal Lyautey, 3 Septembre 1896 :
« Nah Trang est un paradis de végétation tropicale et de climat tempéré, au fond de sa crique, abrité par des falaises orientées comme exprès contre toute violence de mer ou de chaleur.
« Il y a le docteur Yersin. Élève de Pasteur et du docteur Roux, ce jeune médecin de la marine (il n’a pas trente ans) s’est voué à la science microbienne et à la recherche spéciale des vaccins extrême-orientaux avec la foi, la passion des « grands musiciens ». Comme tous ceux qui surgissent, il a trouvé d’abord des montagnes d’obstacles, de doutes et de formalismes. Comme tous ceux qui croient et qui veulent, les Bernard Palissy et les Napoléon, il les a vaincus, les vainc ou les vaincra. Il s’est attelé d’abord aux deux grands fléaux qui ravagent bêtes et gens en Asie : peste bovine et peste humaine dite bubonique.
« Il s’est installé à Nah Trang, dont le laboratoire pasteurien va peut-être devenir historique, parce que Nah Trang est isolé, d’où faculté d’expérimenter sans risque de contaminer une ville de cent mille âmes et d’en soulever les hostilités routinières, parce que c’est à quelques heures de Saigon, des grands bateaux, des communications avec la Chine, avec l’Inde, avec tous les bouillons de culture pestilentiels.
« Il a commencé sans ressource naturellement, il s’’est tout de même procuré vingt chevaux à quinze piastres l’un comme bêtes à vaccin, s’est associé un vétérinaire M. Pesas, qu’il a dressé et enflammé. Et le voilà parti. Et ce sont des heures de réconfort qu’on passe dans cet établissement, encore si rudimentaire, avec ce jeune savant, sans besoins personnels, uniquement possédé par son œuvre. »
A Nah Trang, l’œuvre de Yersin sera superbe autant qu’immense.
D’un vieux blockhaus sur la mer, il se fait un observatoire astronomique, se procure le premier astrolabe à prisme et installe une lunette. C’est dans l’infini des étoiles qu’il puisera son inspiration pour le travail ardu qu’il entreprend : une révolution agronomique, en élevage et en science vétérinaire pour l’Indochine, pour toute l’Asie.
Comme scientifique, Yersin n’a pas de limite, il est intellectuellement bâti et moralement forcené pour franchir toute limite. Il connaît la physique, bien-sûr, et la chimie et les mathématiques (cette dernière discipline lui servant à mieux connaître ses chères étoiles). Il étudie tout. La ferme pilote, centre d’expérimentation qu’il se bâtit à la force du poignet, est alimentée en électricité et en eau potable par une dynamo qu’il a construite. La météorologie, non seulement il la maîtrise, mais il la réinvente : devenant un expérimentateur de premier ordre, il réalise des investigations sur l’électricité atmosphérique.
Quand il entreprend l’agriculture de haute montagne, c’est pour rechercher la capacité des feuilles de conifères à capter l’eau atmosphérique (ce qui expliquerait que les ruisseaux puissent se gonfler au delà de la chute des pluies) et l’activité optique des orchidées.
La ferme même est exceptionnelle. Il doit bien-sûr se lancer dans l’élevage de chevaux pour fabriquer le sérum, activité qui se retrouvera dans tous les Instituts Pasteur du monde, mais il s’intéresse à toutes les autres espèces qui composent ou pourraient composer le cheptel des Indochinois : il s’agit de créer des races plus résistantes, de trouver les agents des maladies qui les affligent (comme la peste bovine) et de trouver remède et vaccin pour chacune.
C’est ainsi qu’il fera le voyage de Normandie avec deux bonnes vaches laitières et un taureau pour les croiser avec des vaches indochinoises très résistantes aux maladies locales, mais pauvres en viande et en lait. Il devra refaire l’expérience deux fois, mais il réussira.
Et comme il faut que les animaux mangent et les expérimentateurs aussi, Yersin se plonge dans l’agronomie et devient un des meilleurs de son temps. Sa station pilote comprend une salle d’opérations, un laboratoire de production de sérum et le plus important... une bibliothèque !
Très vite, il en fera une école pour la formation d’un corps d’élite de vétérinaires annamites. En 1930, il aura un cheptel de plusieurs milliers de bêtes (cochons, bœufs, vaches, moutons, poulets, etc.) et produira sérum, vaccins et médicaments contre les principales maladies humaines et animales de la région.
Il s’essaye à la culture de toutes sortes de plantes : cacao, café, manioc, palme à huile ... acclimatation de légumes européens. Il se lance dans l’établissement de pépinières pour reboiser les forêts. A partir de là, il deviendra un maître dans les maladies des plantes comme dans la microbiologie des sols.
Il met à profit son expérience de défricheur, d’escaladeur et de constructeur de routes pour établir une station à Suoi Giao, ferme qui atteindra 2400 hectares en 1925, puis une station en haute altitude à Hon Ba et enfin deux autres stations en plaine.
Sa passion de l’électricité, de la mécanique, de l’optique, du moteur à combustion, de l’avion, il l’applique partout. D’abord en s’installant tout de suite une TSF au moyen de laquelle, et en utilisant le morse, qu’il connaissait, il pourra communiquer avec ses collègues et élèves dans les autres stations. La première bicyclette puis la toute première voiture automobile de la région seront à lui.
Bientôt, il allie son intérêt pour l’industrie automobile naissante et l’agriculture dans une entreprise qui fera la richesse de l’Indochine : la culture du « Cao-O-Chu » (l’arbre qui pleure). Mais il ne fait rien comme tout le monde : alors que la récolte de caoutchouc s’effectue en d’autres régions en massacrant les arbres et les forêts, il entreprend l’élevage de l’Hévéa Brasiliana scientifiquement :
Trois problèmes d’agronomie devaient être résolus :
- obtenir des arbres de plantation aussi vigoureux que les espèces sauvages ;
- trouver la façon d’entailler l’arbre de manière à obtenir le maximum de caoutchouc, tout en en laissant suffisamment pour que l’arbre puisse continuer à vivre ;
- améliorer la qualité du latex.
Pour tout cela, il avait besoin de main-d’œuvre ; avec son équipe initiale d’Annamites, il nettoie la forêt environnante, non seulement pour ses stations, mais aussi pour offrir à d’autres paysans locaux 150 acres (78 ha) en échange de leur travail dans les stations. Ces 150 acres devaient leur permettre de cultiver du riz, élément principal de l’alimentation locale annamite. Rapidement, dans la plantation pilote d’hévéas, on sait soigner les maladies des hévéas, résoudre le problème de la coagulation du latex, et du choix des graines…
En 1916, ses hévéas produisaient deux tonnes de latex par mois. En dépit du typhon de 1926 qui détruisit les deux tiers de la plantation, en 1943, celle-ci produisait plus de 110 tonnes par an !
La première guerre mondiale amène encore un autre défi : Paris cesse l’envoi de quinine, médicament essentiel pour les pays touchés par la malaria comme l’Indochine. Yersin et son ami Kempf développent donc une plantation de cinchonas pour produire la quinine. En 1931, la station produit 2,5 tonnes d’écorce, ce qui correspond à 137 kg de sulfate de quinine. En 1936, ces chiffres se montent respectivement à 28,5 tonnes et 2045 kg.
Yersin meurt en 1943. Sa tombe a toujours été gardée et fleurie depuis lors, les Vietnamiens conservant une nostalgique mémoire de ce que les étrangers pouvaient apporter d’amour et de dévouement à la science de bâtir. Peut-être faut-il voir dans la tragédie du Vietnam qui a suivi, une rage impériale de détruire cette beauté.
En face d’une telle vie remplie de découvertes, on pourrait se demander si Pasteur exigeait de tout pasteurien qu’il se lance dans des entreprises aussi vastes. La réponse est simple : Pasteur attirait les belles âmes, il leur enseignait sa méthode scientifique en vue de l’apporter aux terres lointaines, le reste était laissé à l’imagination créatrice de l’élève.
Un jour, quelqu’un demanda à Pasteur quel était le but d’une découverte scientifique. Il répondit : « Je vous répondrai avec Benjamin Franklin : A quoi sert l’enfant nouveau-né ? »
La Maîtrise de l’environnement et la lutte contre les moustiques
Dr Emile Roux à L’Université de Lille, le 5 novembre 1898 :
Pour construire un Institut Pasteur, il ne suffit pas de construire des laboratoires de recherche et d’enseignement, munis de l’outillage le plus perfectionné, il faut encore y introduire « l’esprit pasteurien », c’est-à-dire la foi scientifique qui donne l’ardeur au travail, l’imagination qui inspire les idées, la persévérance qui les poursuit, la critique qui les contrôle, la rigueur expérimentale qui les prouve, et aussi l’indépendance et le désintéressement qui sont une conséquence de l’amour passionné de la vérité.
En 1897, quand le pasteurien Simond arrive à Bombay pour seconder Yersin dans ses recherches sur la peste, il montre que les notions communément admises de contagiosité « par l’air, par la peau » sont mal fondées et, pour affirmer ses dires, il met en évidence le rôle des puces des rats dans la transmission de la peste.
Le travail de Simond montre bien que « l’esprit mécanique n’a pas de place en biologie », comme dirait Nicolle. En effet, ce problème de la contagiosité n’était pas évident : d’une part, un rat mort depuis longtemps n’est pas du tout contagieux ; d’autre part, lorsqu’on met un animal sain dans la même cage qu’un animal malade, cela n’entraîne parfois que la transmission de la maladie. En fait, le rat pestiféré n’est contagieux qu’au moment où il meurt. Pourquoi ? Parce que les puces quittent le mourant pour aller sur l’hôte vivant le plus proche. Encore fallait-il y penser et le prouver.
Cette découverte est historique car, à cette époque, le rôle des insectes dans la transmission de certaines maladies contagieuses n’était pas ou peu admis en épidémiologie. Près de vingt ans après les découvertes de Finlay en 1881 sur la transmission de la fièvre jaune par le moustique Culex Fasciatus, les pasteuriens restaient les seuls à prendre au sérieux cette possibilité de transmission. Le Japonais Ogata avait bien émis l’hypothèse d’une transmission de la peste par les puces de rats, mais sans expériences à l’appui et dans l’indifférence générale.
Les preuves que Simond apporte en 1897 vont donc entraîner une seconde révolution en épidémiologie. A partir de ce moment, l’une des principales tâches des chercheurs en microbiologie fut de découvrir quel était l’insecte spécifique qui pouvait transmettre un « microbe » (parasite ou autre) nouvellement identifié. La découverte et les recherches sur les « organismes vivants » à l’origine de la contagiosité des maladies infectieuses devint un « drame merveilleux » : établir qu’un micro-organisme était à l’origine de telle ou telle maladie infectieuse était une chose, montrer l’existence d’un hôte vivant intermédiaire dans la transmission de la maladie fut plus difficile encore.
En 1897, Laveran, médecin militaire célèbre pour sa découverte de l’hématozoaire du paludisme (Constantine, 1880), rejoint l’Institut. En 1907, avec l’argent du Prix Nobel qu’il vient de recevoir, il crée un service spécial. Celui-ci comprend trois grands laboratoires : protozoologie, microbiologie et entomologie médicale dirigés respectivement par Mesnil, Marchand et Roubaud. En 1908, c’est la Société de Pathologie Exotique qui est créée par Laveran et Mesnil, société qui aura une grande importance dans l’œuvre coloniale française et, plus tard, dans l’œuvre de coopération. [1]
Les maladies transmissibles par les insectes sont très spécifiques, en ce sens que des pathogènes, virus ou parasites, se reproduiront dans un insecte qui deviendra le vecteur spécifique de cette maladie. Dans la maladie du sommeil, par exemple, le parasite trypanosome se reproduit dans la mouche tsé-tsé et pas dans un autre insecte.
Ceci était déjà connu lorsqu’un médecin colonial pasteurien du nom de Bouffard fit une autre découverte cruciale : les insectes peuvent aussi être le vecteur « mécanique » de maladies. Mécanique signifie que la plupart des insectes peuvent transporter un pathogène d’un animal ou d’une personne infectés jusqu’à un autre animal ou humain et donc transmettre la maladie à courte distance, dans une courte période de temps. La manière dont Bouffard fit cette découverte est réellement intéressante.
Bouffard emmenait un troupeau de zébus vers sa ferme pour y commencer un élevage de bétail. Le troupeau venait de loin et avait dû traverser des territoires infectés par la mouche tsé-tsé. Quelques jours après leur arrivée, certains animaux tombèrent malades ; il ne fallut pas longtemps à un microbiologiste qualifié comme Bouffard pour découvrir que le sang des animaux mourants était rempli de trypanosomes. Il conclut qu’à l’évidence, ces quelques bêtes avaient été mordues sur le chemin par des mouches tsé-tsé porteuses du trypanosome. Il pensa alors qu’il allait perdre ces bêtes et que l’épidémie s’arrêterait là faute de mouches tsé-tsé, puisqu’il n’y en avait aucune dans toute la région dans laquelle la ferme était située. .
Or, il arriva quelque chose d’extraordinaire : chaque jour, d’autres bêtes tombaient malades. Bouffard devait résoudre ce mystère ou se résoudre à perdre tout son troupeau ! Il pensa alors à une espèce de mouches, les stomoxes, sortes de grosses mouches hématophages, comme porteuses potentielles de la maladie : même si les trypanosomes ne se reproduisaient pas dans les stomoxes, il était possible que ces dernières agissent comme transporteuses de sang infecté d’un animal à l’autre.
Il prit deux veaux qu’il plaça dans deux cages séparées d’une étable fermée et il inocula des trypanosomes à l’un d’entre eux. Une fois que le veau fût bien malade, après quelques jours, il lâcha des stomoxes dans l’étable, de telle manière que les mouches puissent piquer l’animal sain et l’animal infecté. Le veau sain développa à son tour la trypanosomiase. C’était la preuve que des insectes hématophages autres que les mouches tsé-tsé pouvaient transmettre la maladie à courte portée. Ce qui se passe, c’est que lorsqu’une mouche se nourrissant sur un animal malade se trouve dérangée et ne peut « finir son repas », elle va rapidement sur un autre animal voisin pour continuer son repas et transmet le trypanosome à son nouvel hôte. [2]
Pour terminer, il faut encore préciser que la transmission d’une maladie par des insectes peut se faire de deux manières : directe ou indirecte. « Directe » signifie que l’insecte inocule directement l’agent de la maladie ; « indirecte » signifie que l’homme s’inocule lui-même en se grattant ou en écrasant l’insecte infecté qui est en train de le piquer.
Charles Nicolle, dont nous parlerons plus loin, fut le premier expérimentateur à démontrer la transmission indirecte dans le cas du typhus. Les puces infectées par le typhus peuvent mordre un homme plusieurs fois, elles ne lui inoculeront pas la maladie.
Mais si cet homme se gratte, il peut casser une patte de la puce (par exemple) et répandre par inadvertance un peu du sang infecté sur la minuscule plaie provoquée par la morsure de l’insecte, ou bien s’inoculer un peu des excréments souillés que l’insecte a laissé sur sa peau près de la piqûre.
Ceci est également le cas pour la peste bubonique dont la transmission est principalement indirecte.
Les découvertes de frères Sergent en Algérie
- La fièvre récurrente mondiale est transmise par les poux. La récurrente hispano-africaine peut être transmise par les tiques de chiens.
- La leishmaniose cutanée est transmise par un hippoboscidé (diptère pupipare)
- La trypanosomiase du dromadaire nord-africain est transmise par les taons et peut-être par les stomoxes. (Les Bédouins du désert avaient raison de donner à cette maladie le nom de « debab » qui veut dire « taon », et d’éviter scrupuleusement les endroits connus pour être infestés de taons)
- La piroplasmose ou « jaunisse » du bœuf représente non pas une, mais cinq maladies différentes. Les tiques qui transmettent en Algérie les plus meurtrières d’entre ces piroplasmoses sont identifiées.
- Les levures de vin sont propagées dans le vignoble par les drosophiles (Pasteur disait déjà que la fermentation est une « maladie du vin »)
Référence : notice sur l’Institut Pasteur d’Alger
Laveran avait accueilli avec enthousiasme la découverte de Ronald Ross sur le rôle de l’anophèle (espèce de moustique) dans la transmission du paludisme, car il lui avait écrit quelques années auparavant ses suspicions quand au rôle éventuel d’un moustique (d’après les archives de l’Institut Pasteur). Il décide donc de parfaire l’œuvre entreprise en Algérie et envoie une mission ayant pour tâche d’élaborer une campagne d’étude et de prophylaxie du paludisme. Les frères Sergent sont choisis par Roux et Laveran pour mener à bien cette mission. A partir de 1900, ils entament une étude approfondie de la biologie des facteurs animés de toute épidémiologie palustre. Ils détaillent le mécanisme de reproduction de l’hématozoaire chez l’insecte et chez l’homme (voir figure p.18) et établissent le cycle de transmission. Ils montrent que la quinine ne stérilise pas mais confère une immunisation sans risques.
Leurs études sur la vie de l’insecte montrent que les larves passent trois semaines dans des eaux stagnantes, (marais par exemple, paludisme signifie « fièvre des marais ») avant de devenir adultes. Le problème des gîtes à larves d’anophèles se ramène donc à celui de la domestication de l’eau. Il faut éliminer les marais, dépister les sites d’eaux stagnantes et œuvrer pour rendre ces eaux courantes.
Dans les années vingt, les Sergent révolutionnent ainsi la vie en Algérie et jettent les bases d’une agriculture et d’une viticulture florissante. En 1926, ils créent une station expérimentale sur le marécage de la Mitidja « Oued Mendi », marécage de 360 hectares à 25km d’Alger qui servira de terrain à l’expérience projetée par Roux : « prendre une terre inculte rendue inhabitable par le paludisme et montrer que l’on peut d’emblée cultiver le terrain et y vivre en bonne santé. »
Panneau figurant à l’Exposition internationale de 1937 de Paris devenue le Palais de la Découverte
« Le paludisme - Le paludisme de l’homme est dû à des microbes découverts, en 1880, par A. Laveran, à Constantine (1), et qui vivent dans les globules rouges du sang. On en compte trois espèces, qui causent la fièvre tierce maligne (2), la tierce bénigne (3), la fièvre quarte (4).
Il existe aussi des paludismes des oiseaux (passereaux, pigeons) dus à plusieurs microbes (5), (6), (7). Ces paludismes sont particulièrement précieux pour la recherche scientifique et pour l’expérimentation des médicaments antipaludiques.
« Le paludisme de l’homme est transmis par la piqûre de moustiques particuliers, les Anophèles (8) ; le paludisme des passereaux (5), (6), par d’autres moustiques, les Culex (9) ; le paludisme des pigeons (7) par un Hippoboscidé, Lynchia maura (10), qui pond non pas des œufs, mais une pupe (11). (1906)
La lutte contre le paludisme de l’homme consiste : 1) à guérir les paludéens ; 2) à diminuer le nombre des Anophèles ; 3) à protéger les sujets sains contre leurs piqûres.
On guérit les paludéens - facilement reconnus par la palpation de la rate (12), que la maladie fait grossir - en leur administrant un médicament antipaludique (quinine, produit synthétique) (13).
On diminue le nombre des Anophèles par la suppression des eaux stagnantes, où leurs larves se développent, au moyen des fossés de drainage (14), par l’alternance de l’écoulement des eaux (15), par l’épandage sur l’eau de produits insecticides, par l’utilisation de petits poissons, mangeurs de larves, dont on peuple bassins (16), étangs et rivières, etc. ..
On protège les sujets sains contre les piqûres des Anophèles, en munissant les ouvertures des maisons d’habitation (portes, fenêtres) de treillis métallique fin (17), et on détruit les moustiques en pulvérisant des liquides insecticides sur les parois intérieures des locaux. »
Les bases de l’épistémologie en médecine
Les frères Edmond et Etienne Sergent sont les fondateurs de l’Institut Pasteur d’Alger. Leur autre contribution majeure, c’est d’avoir énoncé les bases scientifiques de l’épidémiologie, dans un ouvrage de portée majeure intitulé Réflexions sur les modalités de l’infection. Leur concept central repose sur la découverte de l’affection inapparente, celle de celui qu’on appelle aujourd’hui le porteur asymptomatique, et sur le combat contre la maladie avec une prophylaxie protégeant la population avant que cette maladie n’éclate véritablement. Le but est d’intervenir au moment où la maladie risque de passer de la forme endémique à la forme épidémique ou pandémique.
Cela signifie que le groupe de porteurs asymptomatiques sera circonscrit au point de ne donner qu’un nombre limité de malades qui seront ensuite traités un par un.
Dans la majorité des maladies, le traitement dans la première phase permettra non seulement d’empêcher la forme aiguë et handicapante de la maladie, mais encore de prévenir la contagion au reste de la communauté. Par exemple, la lèpre ou la tuberculose sont hautement infectieuses pendant les stades avancés, beaucoup moins dans la période précédant la phase clinique aiguë.
Les Sergent mettent en avant la notion de seuil de danger, pour une région donnée, qui dépend de trois facteurs :
- le nombre de malades ;
- le nombre de porteurs ;
- le nombre d’insectes.
Dans cette notion est incluse l’idée que ce sont à la fois les vecteurs de transmission et la vitesse à laquelle la maladie se répand qui peuvent accroître la virulence de cette dernière. Si nous prenons la peste pour exemple, la première transmission va de la puce du rat vers l’homme, la seconde va de la puce humaine vers l’homme et, une fois qu’un certain seuil est atteint, on a une transmission pulmonaire par aérosol.
Les Sergent affinent cette notion en discutant les différents modes d’affection à la fois pour les porteurs et pour les malades. L’infection, disent-ils, peut être à la fois passive et active. Passive signifie que le corps est imprégné de germes ; active signifie l’action d’imprégner de germes. Les deux formes d’infections peuvent être dépourvues de signes cliniques. La phase active correspond à ce qu’on appelle aujourd’hui virémie, pour les infections virales.
En résumé, il est important, et même crucial, de distinguer entre la personne qui a des anticorps à une infection virale parce que le virus se « cache » dans quelques unes de ses cellules, et la même personne durant des périodes de virémie lorsqu’elle produit des millions de particules virales et qu’elle est donc hautement contagieuse.
Une infection inapparente peut signifier prémunition aussi bien que non-prémunition. La prémunition veut dire que tant que la personne est infectée par de petites quantités d’hématozoaires, par exemple, elle sera immune contre une « surinfection » de paludisme, mais sera infectieuse pour les autres, ceci sans souffrir de manifestations cliniques. Cependant, dans le cas où le corps se débarrasse de tous ses parasites, la personne est à nouveau en mesure d’attraper la maladie. La non-prémunition est représentée par le cas du SIDA aujourd’hui.
Dans leurs études fondamentales sur les piroplasmoses, les Sergent arrivent à la conclusion suivante :
L’étude expérimentale de la résistance aux surinfections conférée par une première infection a conduit à préciser la notion de prémunition, forme de résistance différente de l’immunité vraie. Un animal infecté par un piroplasmose, s’il survit à l’accès aigu d’invasion et arrive à tolérer ce virus résiste, tant qu’il reste porteur de germes, à des réinoculations du même piroplasmose (loi de préséance). S’il guérit de sa primo-infection, il cesse d’être protégé contre les réinfections. On a tiré de cette conception de la prémunition une conclusion pratique : donner au bovin une infection bénigne, chronique (si possible latente d’emblée) qui lui évitera l’infection grave.
A partir de cette compréhension des modes successifs d’infection, les Sergent déduisent l’importance du dépistage, par test sanguin, dépistage aussi large et systématique que possible utilisant toutes les mesures de détection virales et bactériologiques qui leur étaient accessibles à l’époque. Tout cela était nécessaire, d’après eux, parce que la flambée parasitique et l’apparition de symptômes cliniques pouvaient ne pas coïncider. Il y a immunité lorsque la guérison clinique coïncide avec l’élimination du parasite, dans le cas contraire, il y a prémunition.
Ils identifièrent également le phénomène intéressant de l’antagonisme entre différents microbes.
Nicolle, continuateur de Pasteur
Ce n’est pas la notion de « spécificité » (un microbe = une maladie) qui rend Pasteur si unique, mais ce sont plutôt les postulats de sa méthode :
- La distinction absolue qu’il fait entre l’organique et l’inorganique ;
- La notion que c’est l’organique, la vie elle-même, qui est le paramètre de toutes les autres sciences parce que la vie est la caractéristique de l’Univers ;
- L’idée que le principe « organique » qui se manifeste dans la cicatrisation des plaies est auto-généré, que c’est une dissymétrie générée du dedans.
La vie s’enveloppe sur elle-même, hors d’elle-même. (C’est ce que signifie à l’origine le terme « développement »). Le concept est cusien à l’origine [3] ; bien que nous ne sachions pas si Pasteur connaissait l’œuvre de Nicolas de Cues, il est certain qu’il est parvenu à maîtriser ce concept à travers celle de Léonard de Vinci, que Pasteur jeune peintre connaissait bien. L’organique est dextrogyre et / ou lévogyre (main droite ou gauche) ; cela implique que dans les réactions chimiques, une forme est toujours préférée à une autre.
Quelle est la géométrie qui préside à la création de cette orientation spatiale ?
A priori, une triple rotation est nécessaire. Un processus de croissance ordinaire prend la forme d’une spirale. Le processus de croissance en spirale de base nécessite une double rotation. Un coquillage enroulé à gauche est-il exactement semblable à un coquillage enroulé à droite lorsque l’orientation de l’axe est opposée ? Il Y a une autre manière de regarder le problème. Le lévogyre peut sortir du dextrogyre par un processus de repliement externe (pensez à deux gants).
Pasteur pensait que la compréhension du « pourquoi et comment » des comportements optiques ou électromagnétiques singuliers dans les processus vivants débloquerait le mécanisme clé de l’interaction microbe-tissu. Aujourd’hui la biophysique optique est une voie peu étudiée, et par des gens considérés généralement comme « marginaux » par le monde de la recherche dominé par la biologie moléculaire traditionnelle, comme Pasteur était marginal dans son propre domaine de recherche. [4]
L’importance de Charles Nicolle est d’avoir repris et appliqué ces concepts au développement d’une épidémie ou d’une maladie. Il est sans doute le médecin qui a le mieux présenté, par écrit, la vision pasteurienne de la maladie, poussant plus loin les découvertes du grand homme à l’aide de toutes les connaissances accumulées par ses élèves. Ses pensées sont peu connues en dehors des médecins français associés à l’Institut de Paris car ses écrits n’ont pas été réimprimés.
Nicolle commence son expérience médicale en fondant l’Institut Pasteur de Tunis. Après son retour de Tunis, Nicolle s’aperçut que la médecine française avait complètement banalisé la découverte de Pasteur et que, au lieu de comprendre la maladie comme un processus vivant, elle avait adopté l’approche opposée, l’approche positiviste de l’Encyclopédie : un agent = une maladie = X signes cliniques. Une épidémie était devenue le simple agrégat statistique d’individus malades. Nicolle pensa donc qu’il fallait polémiquer contre cette approche « de catalogue médical » et restaurer une pensée socratique dans la profession. Il accomplit cette tâche dans une série de conférences au Collège de France, publiées plus tard sous le titre de Naissance, vie et mort des maladies infectieuses. Dans ces conférences, il s’élevait vivement contre la décadence impériale du comportement politique de l’Europe, notamment envers les peuples colonisés.
La notion de base que Nicolle présente de manière plutôt poétique est la suivante :
La maladie infectieuse a les caractères de la vie. Elle les doit à sa cause animée et à la réaction des cellules de nos organes qui sont des êtres vivants (...). La maladie comme tout être vivant, vit : elle a une naissance, une vie, une mort.
La maladie doit être perçue comme une créature résultant d’une part de la virulence de l’agent vivant, c’est-à-dire sa capacité à effectuer du travail ; d’autre part le redéploiement de l’organisme cible pour s’auto-restaurer, ou son potentiel d’efficacité plus grande. « La vie, dit-il, est caractérisée par la continuité et son usage des moindres possibilités pour se perpétuer. »
Pour illustrer ce concept, Nicolle se réfère aux expériences de Léonard sur la forme sphérique prise par une goutte de liquide comprise dans un autre liquide non-miscible. Ceci correspond directement au principe de moindre action, développé initialement par Cues, puis par Leibniz. Nicolle ne se réfère pas à ces deux auteurs mais son concept est le même ; il veut dire que la caractéristique de la vie (et donc des pathogènes ou de la maladie) est d’atteindre à une efficacité maximale dans le travail effectué pour se perpétuer.
Ainsi, Nicolle explique que le médecin ne « voit » jamais une maladie, ce qui est une illusion. « La seule chose que nous voyions, c’est un moment dans l’existence d’une maladie » qui subit un double processus d’« évolution » et de « mutation ». Si nous mettons cette idée en termes mathématiques, nous pouvons dire que la maladie n’est compréhensible que comme une fonction riemannienne qui est non linéairement continue, avec une densité de « singularités », ou mutations. Cette fonction riemannienne résulte elle-même de fonctions néguentropiques rivales représentées par le « microbe » qui cherche l’efficacité maximale, ou la « virulence », et le contre-déploiement de l’hôte qui fait de même. La « virulence » est interdépendante en raison inverse de la maîtrise de l’homme sur son environnement ou de son bien-être économique.
C’est ce type de raisonnement qui pousse Nicolle à faire l’hypothèse, et il précise bien que ce n’est qu’une hypothèse, que les virus sont les descendants des bactéries. Son argument est que le virus qui ne se réplique que dans des organismes supérieurs est plus « efficace », de son point de vue, que la bactérie qui se satisfait d’un milieu nutritif. De la bactérie au virus, il y a un bond en termes de capacité de travail. Que l’hypothèse de Nicolle soit vérifiable ou non, son concept est très important et va à l’encontre de la biologie moléculaire actuelle qui affirme que le virus est « mort » ; elle le fait parce que sa description, son concept de la vie sont linéaires et qu’elle cherche à expliquer la vie du point de vue de l’inorganique plutôt que l’inverse. Nicolle dit :
Comme telle, la maladie à trois modes d’existence : individuelle : elle naît, vit et meurt dans un individu ; collective : elle touche un groupe, passe de l’un à l’autre, fait le tour du monde ; historique : sa vie à travers les âges.
Nicolle a une approche dynamique : en discutant les relations de cause à effet non-linéaires, il montre comment on ne peut aboutir à la connaissance d’une maladie en imaginant un microbe comme une entité « fixe » ayant dès « effets fixes » dans un « cadre de temps fixe ». Il voit plutôt la maladie dans son existence spatio-temporelle : c’est la manière dont elle se « développe » qui représente son existence. Qui plus est, un microbe ne vient jamais seul, mais amène toujours d’autres micro-organismes dont la virulence latente se recombine avec la virulence première. Pour Nicolle, l’existence « inapparente », celle qui n’est pas associée à des signes cliniques n’est pas propre à une catégorie séparée de « porteurs sains » mais représente plutôt une partie de fonction continue, fonction qu’il est primordial de situer dans la vie « historique » ou « collective » d’une maladie. Une épidémie n’est pas composée d’une somme d’individus malades, elle est formée, elle se déroule comme un tout, comme un organisme vivant, de forme invisible pendant des années avant d’apparaître dans le domaine « visible ».
Nicolle nous fait comprendre la pensée non-mécanique qui est à l’origine de toutes les grandes découvertes scientifiques en médecine. Il déclare clairement que « la pensée mécanique est inappropriée aux sciences biologiques ». Duclaux disait la même chose.
La maladie est un processus vivant évoluant non-linéairement ; il en est de même pour ses modes de transmission. Il est temps maintenant de regarder le cas du SIDA avant d’examiner les conséquences de la vision pasteurienne de Nicolle sur le traitement et la prévention des épidémies.
Si l’on regarde le cas du SIDA, il faut le faire du point de vue de la méthode socratique cusienne : savoir, c’est désapprendre.
Nous connaissons l’agent du SIDA, ce qui est crucial, mais il n’est qu’un moment de notre connaissance, un moment dans l’existence de la maladie. L’agent évolue selon l’individu, selon le tissu ou l’organe touché [5] et selon la population.
Cet agent peut évoluer également dans d’autres virus : HIV2 est-il un mutant de HIV 1ou HIV 3 ? Y a-t-il eu une base commune à partir de laquelle ces trois virus se sont développés ? Qu’en est-il des malades du Sénégal qui sont infectés à la fois par HIV 1 et HIV 2 ? Toutes ces questions restent encore en suspens.
Il y a également évolution de la virulence, ou du pouvoir à effectuer des changements dans l’interaction virus / organisme et dans l’interaction au sein des populations lors de pandémies.
Le HIV peut infecter :
- les lymphocytes
- les cellules épithéliales
- les macrophages
- les cellules microgliales
- les cellules de Langerhans
- et d’autres, dont les neurones.
Tout ceci entraîne une multiplicité d’interaction dont la plus essentielle semble être l’interaction système neurologique-système immunitaire ; on sait aujourd’hui que le HIV effectue des changements dans l’activité cérébrale et qu’en retour, le dérangement neurologique modifie le fonctionnement du système immunitaire.
Il y a enfin interaction entre virulences : Qu’est ce qui fait que certaines maladies sont associées aux sidéens (les fameuses maladies « opportunistes ») ? Qu’est ce que la pneumocystia en commun avec le sarcome de Kaposi ?
L’idée d’un processus de lyse HIV-lymphocytes, puis de dépression immunitaire et enfin d’infection opportuniste est une idée fixe que nous devons d’abord réfuter, en redéfinissant la véritable nature de la déficience immunitaire, pour retrouver ensuite la part de vérité qu’elle peut éventuellement contenir. [6]
Nicolle n’utilise pas le terme de « plus grande efficacité » mais plutôt celle « d’équilibre » ; ceci indique qu’il n’a pas osé s’attaquer ou qu’il n’a pas cherché à redéfinir les concepts linéaires dérivés de la physique de son époque, eu égard à son approche de la vie. Il dépend de nous de le faire en reprenant celle-ci qui est une application très importante de la méthode socratique à la médecine.
En fait, comment pourrions-nous redéfinir la santé d’un individu ?
Ma propre expérience, modeste, mais qui a été celle de toute ma vie jusqu’à aujourd’hui, d’avoir dû, à cause d’une polio infantile (contractée à l’âge de 9 mois), vivre avec une force musculaire réduite à 20 % de la normale, m’a conduite à réfuter, non pas en mots mais en faits, l’idée qu’il existerait un équilibre normal en tant que tel, ou que l’homme parviendrait à son maximum à l’âge de vingt ans et qu’ensuite, il déclinerait.
II n’y a pas d’équilibre, l’homme doit croître pour exister.
En fait, lorsque nous cherchons à mieux comprendre l’activité métabolique, nous voyons que l’action enzymatique produit plus d’énergie que « nécessaire », un phénomène bien connu qui viole le deuxième principe de la thermodynamique auquel les biologistes moléculaires d’aujourd’hui sont attachés comme à la queue de Satan.
L’homme produit de l’énergie libre jusqu’à sa mort. Voilà ce que je retire de mon expérience. De plus, l’énergie nécessaire pour maintenir le mouvement aussi bien que le métabolisme interne s’accroit avec l’âge, demandant une plus grande efficacité énergétique totale pour maintenir l’énergie libre au delà de la quantité totale grandissante requise pour la vie du système. Alors que le rapport de l’énergie libre sur énergie totale du système décroît avec l’âge, comme le montre la perte d’efficacité musculaire, il est nécessaire de prendre en considération l’évolution mentale.
Si l’on met de côté la question de la sénilité, qui s’avère être due à des maladies virales ou autres, les personnes âgées perdent peu à peu leur capacité de mémorisation mais voient s’accroître leur capacité d’activité mentale synthétique. Il y a un changement de phase dans la capacité mentale, qui gagne en profondeur ; la capacité réflexive devient supérieure alors que l’énergie libre physique décroît.
Ce qui est vrai du « savant » l’est aussi pour l’ensemble des personnes âgées, ce qui rend particulièrement odieux le crime de l’euthanasie.
Le rôle des grands-parents dans une société apparaît alors sous un jour nouveau : ils sont très souvent la source la plus exquise d’un « enseignement réel », c’est-à-dire d’une géométrie synthétique de pensée pour l’enfant.
Dans une belle âme, la raison et l’émotion se sont mariées et à l’âge de soixante cinq ans environ, la personne douée de cette belle âme apparaît libre de créer une nouvelle liberté, celle qui se manifeste par la « joie ». Joie, maîtrise de la création de « l’ironie ». Ironie, qui est à la fois forme poétique quotidienne et pierre angulaire de ce qui fait une découverte scientifique. Ironie, étonnement devant le monde à découvrir et amour du risque pris pour explorer cet inconnu.
De Calmette à Jamot : les organisateurs de la victoire
Dans les entreprises guerrières « belliqueuses », se montrent toutes choses grandes et belles, comme disait Rabelais : « Belliqueux » vient de « belle cose » (belles choses en Italien). C’est alors que le citoyen s’éveille et se met au travail, c’est alors que l’homme de courage, l’homme grand, se distingue du pleutre et du lâche. C’est merveille de voir la cité s’éveiller dans une symphonie d’activités, disait-il.
La médecine militaire française fut belliqueuse à outrance :
Et si le salut l’exigeait, il ne faudrait pas hésiter à créer cet État dans l’État, dût l’orgueil déplacé de certains en souffrir. (Jamot. Rapport final – 1935)
La première initiative remonte à Colbert, avec les écoles de Brest, Rochefort et Toulon, mais c’est en 1890 qu’un gouvernement dirigé par Sadi Carnot répond à l’idée de Louis Pasteur, et que se créent le « Corps de Santé Colonial » et « l’École de Santé Navale de Bordeaux ». Le secrétaire d’État aux colonies Etienne en décidait ainsi, au moment même où il lance avec Pasteur le premier Institut d’outre-mer à Saigon. Plus tard, en 1905, se crée l’École d’Application du Service de Santé des troupes coloniales, le Pharo, à Marseille.
Ce qu’il y a d’exceptionnel dans la médecine militaire coloniale de cette époque, c’est d’une part l’esprit de corps qui y règne, et d’autre part, la qualité scientifique de ses élites.
Comme nous vivons une période de désintégration morale et d’égoïsme absolu, cet esprit de corps militaire pasteurien nous semble étranger ; il est incompris alors même qu’au plus profond de l’esprit humain, la voix de la Beauté et de la Raison l’appelle et l’exige.
Le système de santé britannique mis en place aux Indes et en Afrique fut un système de « contrats temporaires renouvelables », c’est-à-dire que l’essentiel du personnel de santé y était « commissionné ». C’est exactement la façon dont l’OMS fonctionne aujourd’hui. Cela entraîne deux faiblesses majeures : premièrement le commandement étant mal délimité, l’excellence voisine avec le pire ; deuxièmement, la transmission de l’expertise est impossible.
A l’inverse, les recrues du Corps de Santé Colonial recevaient une formation pluridisciplinaire (médecine, sciences naturelles et chimie), une véritable formation d’écologistes, dans une même école, avec le même dessein : apporter mieux-être aux habitants des pays tropicaux, les soigner, mais aussi découvrir, apprendre et enseigner. Ces études, les plus exigeantes de leur époque, comptaient lors de l’examen final la réalisation d’un « chef d’œuvre », un travail d’anatomie et de chirurgie. Les professeurs venaient tout droit des colonies, des hommes trempés dans l’action sur le terrain, qui avaient fait leur temps « en brousse » et sur les villes côtières. Ils enseignaient trois ans, puis repartaient en mission. La recrue savait que, l’examen passé et réussi, elle devrait aller passer deux années obligatoires en brousse, ce qui demandait certainement un grand courage physique et une passion pour l’aventure ... à risques ! On est loin de l’ivresse dégradante du « Paris-Dakar ». La survie physique n’étant pas garantie, partir en brousse équivalait à partir en guerre, avec la restriction que dans cette guerre, seul le bien était de rigueur.
Les fils de bourgeois cherchant carrière, les fils de pauvres voulant réussir financièrement, tout douillet s’abstenir ! Le médecin civil parfois envoyé dans une colonie gagnait jusqu’à quatre fois plus que le médecin militaire déjà sur place. Les Ecoles de Santé Coloniale étaient faites pour ceux que l’argent et la réussite financière ne concernaient pas. Les recrues y entraient pour un idéal : science et action. Celles qui ne réussissaient pas tout-à-fait leur chef d’œuvre d’examen, ou celles qui, de constitution délicate, ne supportaient pas longtemps les rigueurs tropicales, se retrouvaient médecins de campagne. C’est ainsi que la population rurale de la France, dont le niveau de santé, de vie et d’hygiène n’était, à l’époque, pas beaucoup plus élevé que celui des villageois des colonies, s’est trouvé radicalement transformée.
Calmette, médecin sentinelle
Calmette, enfant, voulait être marin. C’est ainsi qu’il se dirige en 1881, à l’âge de dix-huit ans, vers l’Ecole de Santé Navale de Brest. Comme tout élève passés les premiers examens, il doit aller en mission avec la Marine, comme aide-médecin de deuxième classe avant de pouvoir devenir candidat au doctorat. Il s’engage avec l’amiral Courbet qui dirige la marine française dans la guerre avec la Chine. Cette guerre qui commença en novembre 1883 se terminera avec la conquête de l’Annam et du Tonkin.
Durant l’expédition, Calmette s’informe du déroulement des opérations militaires et participe aux discussions politiques ; mais il fait aussi une étude intéressante sur l’éléphantiasis qui affecte 10 % de la population de Shanghai. Il traduit ainsi le travail de Manson sur la filiaire de Bankroft (parasite responsable de l’éléphantiasis) et sur le rôle du moustique comme hôte intermédiaire de la filaire, idée révolutionnaire pour l’époque. De retour en métropole en 1885, il consacre sa thèse de doctorat à cette maladie.
En 1887, il repart au Gabon avec Brazza. Là, devant l’insalubrité de la colonie, il envisage les réalisations exceptionnelles qui pourraient résulter d’une médecine organisée, dotée de crédits illimités, pour en faire un pays prospère, et soumet son rapport aux autorités coloniales.
En 1888, suite à son mariage, il retourne au pays, mais ce n’est que pour en repartir à destination de Saint Pierre et Miquelon, où il s’initie aux techniques bactériologiques en autodidacte. A l’automne 1890, le voilà à l’Institut Pasteur, brillant élève du cours de Roux. Quelques mois plus tard, il accepte la mission pour Saigon dont nous avons parlé plus haut.
J’ai exposé à M. Treille l’intérêt scientifique que présentait l’organisation à Saigon d’un institut en petit, mais sérieusement reconstitué et outillé. ( ... ) Il s’est littéralement emballé et a emballé avec lui tous les Bureaux de l’administration des colonies. On m’a fait acheter, séance tenante et sans adjudication, tous les instruments que j’ai voulus, autoclaves, étuves, verrerie, produits chimiques, même un appareil microphotographique. ( ... ) J’emporte aussi vingt quatre cobayes pour constituer un élevage ...
Il s’embarque en janvier 1891 et il installe son laboratoire dans une dépendance de l’hôpital militaire local. Au bout de deux ans et demi, l’Institut produisait d’énormes quantités de vaccins contre la variole, et contre la rage. Calmette a étudié là-bas le choléra et les dysenteries ; il isola les levures nécessaires à la production d’alcool de riz. Enfin, suite à ses études sur les venins, l’Institut de Saigon inaugura la sérothérapie antivenimeuse. Bref, c’est déjà l’émule de Pasteur : s’occuper de tout ce qui concerne le développement d’un pays. Seul un homme de cette trempe pouvait enthousiasmer suffisamment Yersin pour le ramener dans le camp des pasteuriens, comme nous l’avons vu dans le Chapitre II.
Lorsqu’il est de retour à Paris, il pousse son frère, directeur du Figaro, à lancer une souscription nationale afin que l’Institut de Paris dispose enfin des chevaux nécessaires à la sérothérapie antidiphtérique. Il accepte alors un nouveau défi : créer l’Institut Pasteur à Lille, qui prendrait la responsabilité du développement économique et humain de la principale région industrielle de France. L’Institut de Lille, inauguré en 1899, sera un « modèle d’application de la recherche scientifique aux besoins d’un pays déterminé ». Il deviendra un centre de recherche scientifique, un institut d’enseignement et le prototype pour la création d’Instituts outre-mer. Si le missionnaire pasteurien arrivait souvent dans les colonies muni uniquement d’un microscope, d’un sac à dos, et, si possible d’une vache (pour la vaccination contre la variole), si les débuts de l’Institut Pasteur à l’étranger prenaient souvent la forme de simples baraques, le but final, comme l’illustre le cas de Yersin, était la construction des stations d’élevage, des hôpitaux et des laboratoires pilotes les plus modernes.
Cette conception venait en partie de Calmette. Ce dernier estimait en effet que les laboratoires des pays tropicaux devaient assumer des responsabilités majeures dans le développement de sa région et qu’un Institut ne méritait pas son nom s’il n’accomplissait pas ces tâches industrielles et agricoles et s’il n’enseignait pas la méthode scientifique pasteurienne. Ainsi, par agrément entre le Corps de Santé Colonial et l’Institut Pasteur, les candidats aux colonies devaient passer plusieurs mois à Lille où ils étaient accoutumés et formés à de nombreuses technologies.
Lille enseignait aux médecins coloniaux un ensemble de sciences si vaste qu’on peut hésiter à les appeler encore « médecins », scientifiques de la Renaissance ou apprentis scientifiques de la science du vivant pouvant être de meilleurs termes. On étudiait à Lille :
- Microbiologie et pathologie des zones tropicales et tempérées.
- Epizootie animale, études des maladies des animaux sauvages et domestiques, élevage de bétail.
- Etudes des fermentations, entraînement à l’industrie de la bière, du vin et des produits laitiers.
- Aménagements hydrauliques, épurations biologiques de l’eau usée.
- Développement agricole, virus des plantes et bactéries du sol qui améliorent la croissance des plantes.
Il faut souligner la responsabilité mondiale assumée par Lille en ce qui concerne la formation des médecins civils et militaires envoyés en mission en Afrique ou en Indochine.
Les exploits de Lille
Puisque la région abondait en industries de la fermentation (deux tiers des brasseries et des distilleries françaises), il n’y avait qu’à faire comme Pasteur.
« Certaines salles du nouvel Institut furent donc disposées et outillées de manière à permettre d’effectuer toutes sortes d’expériences relatives aux fermentations alcooliques, à la brasserie, à la distillerie, à la sucrerie, à la stérilisation industrielle des eaux. Dès que les crédits le permirent, le laboratoire de microbie agricole dota l’agriculture du Nord d’un rouage analogue à ceux que possédaient alors les grandes institutions agronomiques allemandes. L’outillage comprenait : 1) Un laboratoire de chimie et de microbiologie agricole ; 2) Une halle de végétation dans laquelle pouvait être faites des cultures en pots, des expériences relatives à la chimie et à la microbiologie du sol, ainsi que des démonstrations pratiques et des applications rationnelles d’engrais chimiques ... (microbes de nitrification, engrais catalytiques, etc.)
Il fallait répondre aux appels des médecins praticiens et des services publics pour tous les diagnostics microbiologiques, les enquêtes épidémiologiques, les sérodiagnostics ... Ce fut le rôle du laboratoire de microbie médicale, tandis que celui de microbie vétérinaire rendait les mêmes services pour les maladies des animaux (productions de sérums, vaccins, etc.) Le laboratoire d’hygiène et de chimie appliquée assurait les analyses microbiologiques et chimiques des eaux de boisson. Il traitait de la question de l’épuration des eaux résiduelles et des eaux industrielles. Les problèmes les plus divers étaient traités : assainissement des villes et des campagnes, lutte contre les taudis, amélioration des logements ouvriers dans les quartiers surpeuplés, hygiène des établissements dangereux par la diffusion des maladies contagieuses (cafés, salons de coiffure, alimentation), industries insalubres, contamination des eaux souterraines, destruction des ordures ménagères, etc.
Le laboratoire de physique biologique étudiait l’ozone, l’action des rayons ultra-violets et des rayons X, le chauffage par électricité ou par le gaz, ainsi que les appareils permettant d’obtenir des températures constantes ...
Le laboratoire de chimie physiologique travaillait sur la séroanaphylaxie, l’immunité, les venins, les antitoxines, etc. »
Noël .Bernard et Léopold Nègre (deux proches collaborateurs de Calmette) : Albert Calmette, sa vie et son œuvre scientifique, Masson, 1939.
La prophylaxie contre la tuberculose
L’autre contribution moins connue de Lille, c’est la campagne de prophylaxie exemplaire organisée et mise en place par Calmette durant vingt ans, pendant lesquels, il travailla à l’élaboration d’un vaccin. Le BCG signifie « Bacille Calmette-Guérin », Guérin ayant été son associé dans l’effort de vingt années pour effectuer une mutation dans le bacille de Koch, l’agent de la tuberculose. Environ deux cent cinquante « passages » furent réalisés sur des animaux avant que l’agent microbien ne commence une irréversible mutation, le rendant approprié pour la vaccination.
Au moment de l’effort de Calmette, la tuberculose était le principal « tueur » du cœur industriel de l’Europe, débilitant la force de travail de France, de Belgique, du Luxembourg et d’Allemagne.
« C’est pendant mon séjour à Lille, écrit Calmette, que le problème de la lutte scientifique et sociale contre la tuberculose devint pour moi une véritable obsession. J’étais mieux placé que quiconque pour mesurer toute l’étendue des misères et des ruines causées par cette maladie dans les milieux ouvriers, et je pouvais constater chaque jour l’inutilité ou l’inefficacité des efforts, d’ailleurs mal coordonnés, des institutions de bienfaisance publique et des œuvres d’initiative privée. « Les travailleurs tuberculeux » ne pouvant plus gagner leur vie ni subvenir aux besoins de leur famille, humiliés ou las de solliciter des aumônes, continuent à travailler jusqu’à ce que leurs forces les trahissent, puis s’arrêtent, attendant d’être cloués définitivement sur leur grabat. »
En 1904, Calmette crée donc la Ligue du Nord contre la Tuberculose et établit le préventorium Emile Roux.
« Il me parut indispensable de créer un organisme adapté à la recherche des malades, car, à l’époque où ces malades sont le plus contagieux, ils continuent presque toujours à vivre la vie de tout le monde, fréquentant les ateliers, les usines, ne se doutant en aucune manière eux-mêmes des dangers que présente, pour leur entourage, le mal dont ils sont atteints. »
Le BCG ne serait prêt qu’en 1924. Calmette, considérant les bonnes dames de charité comme ineptes, il les remplaça par des travailleurs industriels qu’il forma à l’Institut pour les engager dans une vaste opération volontaire destinée à tester la population et trouver les personnes infectieuses, qu’elles soient ou non malades. La prophylaxie du lieu de travail vis à vis des personnes contagieuses établissait qu’elles devaient se retirer lorsqu’elles travaillaient dans un endroit où elles ne pourraient pas mettre en danger d’autres personnes. La prophylaxie du foyer incluait la séparation des enfants lorsque les parents devenaient trop infectieux et l’éducation de la famille et des patients sur les moyens de transmission de la tuberculose (moyens sur lesquels Calmette fut le premier à faire des recherches), éducation sur le danger de cracher, de balayer le sol avec une brosse sèche, etc.
Enfin, le préventorium fournissait une assistance sociale : nourriture aux nécessiteux, aide ménagère, aide infirmière, logement, aide financière, et même service de lavage (jusqu’à 8000 kg !) Calmette fut violemment pris à partie et dénoncé par le corps médical lillois pour sa guerre à la tuberculose.
Si Calmette visitait New-York aujourd’hui, comme il serait frappé d’horreur à la vue d’une société riche, laissant des mendiants infectés par la tuberculose dormir dans les rues, aux côtés des demeurés mentaux qui ont été chassés des hôpitaux psychiatriques, pour des raisons financières, il y a une dizaine d’années. Il serait également horrifié de voir la communauté médicale refuser études épidémiologiques et mesures de santé publique contre le SIDA. Il se rappellerait surement ses contradicteurs et ceux de Pasteur, qui préféraient parler des facteurs « sociologiques » ou « météorologiques » ainsi que du « droit des tuberculeux à être laissés en paix » (pour mourir).
La Ligue atteignit son objectif : empêcher l’expansion de la tuberculose et protéger le lieu de travail et la famille, ceci dans la période de vingt ans qui précéda la découverte du BCG.
La guerre à la maladie du sommeil
J’avoue que je n’ai jamais songé, en pensant à une maladie, à lui trouver un remède, mais toujours au contraire à trouver une méthode capable de la prévenir.
Louis Pasteur.Depuis quelques années la Maladie du Sommeil s’est développée en Afrique Equatoriale avec une gravité exceptionnelle. Elle ravage, sans épargner les Blancs, des régions entières. Si un moyen n’est pas découvert, si des mesures prophylactiques ne sont pas adoptées, les énormes sacrifices en hommes et en argent consentis par les métropoles européennes pour pénétrer le Continent noir n’aboutiront qu’à un désastre.
Rapport de la Mission d’Etudes de la Maladie du Sommeil au Congo français. Gustave Martin, Leboeuf et Roubaud. 1906-1908
En 1905, le Dr André Thiroux, qui avait créé le laboratoire et le centre de vaccination de Tananarive, à Madagascar, prit la direction du laboratoire de Saint-Louis du Sénégal pour y étudier la maladie du Sommeil. Saint-Louis était le premier laboratoire d’Afrique noire établi par le Dr Marchoux (1862-1943) en 1896. Marchoux est tellement renommé pour son travail sur la lèpre que le principal Institut Pasteur destiné au traitement et à la recherche sur la lèpre, celui du Mali, porte son nom aujourd’hui : il s’agit de l’Institut Marchoux de Bamako.
A peine était-il arrivé au Sénégal que Thiroux commençait une mission destinée à explorer la région de Niayes, très marécageuse.
En trois semaines, il établit :
- La carte des glossines (c’est-à-dire de la répartition géographique des mouches tsé-tsé) et des cours d’eau à épurer.
- La carte des villages infectés.
- La carte des différents stades de l’infection : nombre de malades et nombres de porteurs par village.
L’évolution des différents stades de la maladie chez les personnes infectées. A partir delà, et mis à part les mesures de contrôle des insectes, il décida qu’une certaine forme de quarantaine était nécessaire, pour abaisser le potentiel de déploiement de la maladie.
En fait, si la ou les personnes infectées (identifiées par test sanguin) continuaient à résider au village, l’infection se répandrait. Il créa donc un village-hôpital dans les environs de Saint-Louis où les sujets affligés par la maladie du sommeil puissent séjourner de manière volontaire. Les structures du village le rendaient plus accueillant aux malades puisqu’ils pouvaient y mener une vie de travail normale, du moins autant que le leur permettait la maladie.
Ce village de ségrégation, comme on l’appelait, devint extrêmement utile en tant que laboratoire de recherche scientifique expérimentale sur la maladie. Thiroux fut le premier à identifier les manifestations neurologiques de la maladie du sommeil ; il fit une communication sur cette question lors du congrès international de psychiatrie de Bruxelles en 1910.
C’est également ce village qui permit à Thiroux d’expérimenter et d’améliorer son traitement de la maladie qui était jusque là incurable.
Jamot : la guerre aux épidémies
Le fondateur de l’épidémiologie militaire qui vise à préserver des populations entières contre des fléaux est sans conteste Eugène Jamot. Diplômé de l’Ecole du Pharo, puis élève de Mesnil à l’Institut Pasteur, il prendra la responsabilité de la lutte contre la terrible maladie du Sommeil en Afrique Occidentale Française (AOF), puis en Afrique Equatoriale (AEF).
C’est en 1916, quand il devient directeur de l’Institut Pasteur de Brazzaville (qui avait été dirigé par Gustave Martin), qu’il forme la notion d’une médecine mobile, comme une armée mobile, qui va aller voir les populations, dépister les trypanosomés par analyse systématique du sang et du liquide céphalo-rachidien. En tout et pour tout, Jamot, qui lance sa première équipe au Cameroun, aura deux auxiliaires Européens non médecins et sept Africains analphabètes, qu’il formera aux actes essentiels de dépistage en trois mois, à l’IP de Brazzaville (savoir reconnaître un trypanosome sous une lame de microscope, savoir faire une injection, etc.). Au fur et à mesure, les trypanosomés seront « blanchis » à l’Atoxii. Son équipe, qui ne connaît ni dimanches ni jours de fêtes, et voyage tout le temps dans la brousse, devra dépister des dizaines de milliers, bientôt des centaines de milliers de malades. Ensuite Jamot sera à même de former d’autres équipes, d’envoyer ces premières recrues africaines dans d’autres pays pour en former de nouvelles. Jamot l’éducateur tient déjà du génie.
Son continuateur, et fondateur de l’Organisation commune de lutte contre les grandes endémies (OCCGE), Pierre Richet, raconte :
C’est en Janvier 1933 que j’ai connu Jamot au cours de mon premier séjour en Afrique alors que j’étais le Médecin chef du rude cercle sahélien de N’Guigmi... près de la rive nord du Lac Tchad ... Il arrive un matin ... Son but ? Délimiter la frontière orientale du sommeil au Niger... Il ne passa que quelques journées parmi nous au cours desquelles nous prospectâmes toute la population. C’était mon premier contact avec l’homme et avec sa doctrine. Il irradiait de bonté, d’indulgence, du plaisir d’expliquer, de former le néophyte ; j’en fus profondément marqué ...
Jamot allait dévoiler le désastre que les « cloportes » (comme il les appelait), les administrateurs coloniaux, s’efforçaient de cacher : en 1916 la maladie du Sommeil éclatait partout, en Oubangui jusqu’à 90 % des populations étaient infestées.
Qui était Jamot ?
Durant la première guerre mondiale, Jamot prit part aux opérations militaires, notamment dans la lutte contre l’armée allemande au Cameroun, qui devint ainsi, après guerre, une colonie française. II perçoit alors la menace posée par la maladie du sommeil sur le continent.
Et il revient au principe de la « Mission » : aller là où sont les hommes, sur le terrain, pour rechercher où est la maladie, comment elle se propage. Mais il combine ce principe à sa connaissance du déploiement militaire moderne nouvellement acquise.
Ce qui va germer dans son esprit est remarquable : l’idée de Pasteur qui est de « prévenir » s’associe aux notions de Nicolle, que tous ces hommes partageaient par ailleurs, l’ennemi microbien est vivant, l’épidémie se déploie comme le fait une armée ennemie. En tant que colonel, il a des notions de « renseignement », d’opération de flanc, et d’opération d’encerclement de l’ennemi. Enfin, rien du bureaucrate chez lui, l’homme de culture croît en l’homme, il est éducateur par excellence.
Or il sait, il voit, qu’il n’y a pas de développement économique possible sans contrôle épidémiologique, c’était déjà la conclusion de rapport de la Mission Martin, Leboeuf, et Roubaud en 1908, les terribles exemples du Canal du Panama d’une part (car le Canal est mort, plus des épidémies que du prétendu scandale financier, au tournant du siècle), et des bouleversements occasionnés par le développement des voies de communication, d’autre part, le démontrent assez.
(La terrible hécatombe parmi les travailleurs qui seront recrutés de diverses régions pour construire le chemin de fer Congo Océan (30 % de mortalité) de 1925 à 38, ne le démentiront pas - Ndlr)
Le brassage des populations, dû au recrutement de bataillons africains dans la première guerre mondiale, s’ajoutant aux bouleversements économiques et commerciaux, ont fait sortir la maladie du sommeil de partout.
Cette trypanosomiase qui a été l’un des premiers sujets de recherche des pasteuriens en Afrique, cette terrible maladie sur laquelle Mesnil, l’éducateur et ami de Jamot à l’Institut, s’est penché, et qui fut le centre de recherche de l’IP de Brazzaville, cette maladie flambe sur toute l’Afrique de l’Ouest et l’Afrique Equatoriale : elle menace de dépeupler le continent.
Jamot le sait à cause des Missions, Jamot le voit, Jamot le sait aussi parce qu’il a le courage de le savoir.
Nous sommes en 1917, il envisage donc une médecine mobile. Il envisage une opération de type militaire, une opération belliqueuse : le dépistage systématique de toute la population concernée, ou potentiellement concernée.
Il s’agit de voir là où l’ennemi se cache, dans l’infecté qui n’est pas encore sommeilleux, et qui infecte des dizaines de glossines qui vont aller contaminer le reste du village. Si rien n’est fait, en quelques mois, il ne restera plus rien, plus personne au village. . {{}}
Jamot ne confond pas, comme nos autorités médicales actuelles, l’agent pathogène de la maladie, et le malade : l’ennemi c’est le parasite, le trypanosome, l’ennemi c’est la contagiosité qui s’ignore, dépister est dans l’intérêt même du malade, et dans l’intérêt de la population encore saine, qu’il faut absolument protéger de la contagion. Déjà les frères Sergent avaient organisé le dépistage systématique des porteurs asymptomatiques du paludisme, maladie autrement moins grave.
Or on sait depuis presque dix ans que la trypanosomiase se transmet par la mouche Tsé-tsé. Or l’Atoxil est arrivé sur le marché, c’est un médicament qui ne guérit pas, quand le parasite est déjà passé dans le liquide céphalo-rachidien, c’est un médicament qui « blanchit » le malade, c’est à dire le rend non contagieux.
En 1917, le gouverneur de l’AEF accorde à Jamot ce qu’il demande : la région sera divisée en districts de prophylaxie, et les villageois seront périodiquement rassemblés dans la brousse, en certains endroits, pour l’arrivée des équipes mobiles.
La première équipe mobile va donc dépister et blanchir. Cela stoppait la contagiosité du sujet ainsi traité, mais n’arrêtait la progression de la maladie que dans la phase initiale. Ceux dont le LCR était déjà infesté développaient la maladie. Dès que les premiers traitements arrivèrent, Jamot voulu traiter tous les Africains, et polémiqua violemment contre une administration réfractaire :
« Je ne pense pas qu’un médecin qui contracterait la maladie, s’accommoderait d’une telle thérapeutique (le blanchissement à l’Atoxil), et sans vouloir établir de comparaison désobligeante pour qui que ce soit entre les blancs et les noirs de ce pays, je ne vois pas pourquoi nous ne ferions pas pour ceux-ci ce que nous exigerions pour nous. ( ... ) Pour en finir avec le fléau, il faut non pas masquer le mal en blanchissant les malades mais guérir tous ceux qui sont curables. ( ... ) »
Jamot commence par la route reliant le bassin de l’Oubangui à celui du Chari, longue d’environ 1000 km. Il fallait visiter tous les villages et passer environ 100000 personnes au crible. Cela dura d’août 1917 à mai 1919. En mars 1922, Jamot est affecté au Cameroun. Dans les foyers du Haut Nyong, la maladie du Sommeil touchait jusqu’à 30% de la population :
« Dans certains groupements de villages nous étions stupéfaits de constater que 97% des sujets étaient déjà infestés, des villages entiers avaient disparus ou s’apprêtaient à disparaître. ( ... ) Le mal se propageait vers l’Ouest comme un feu de brousse. » En 1931, à la tête du service de prophylaxie, au moment où l’on avait découvert plus de cinquante types de trypanosomes, il se promit de nettoyer le reste de l’Afrique de cette épidémie.
A partir de Ouagadougou, capitale de la Haute-Volta et centre administratif du Soudan français, du Niger et de la Côte d’Ivoire., il organisa des brigades de prophylaxie sur le modèle de celles qu’il avait mises en place au Cameroun, et recruta de l’aide médicale sur le terrain.
Malgré une œuvre admirable, Jamot fut l’objet de violentes attaques et par deux fois interdit de séjour en Afrique. [7]
Les fameux principes de Jamot, véritable bible de tout médecin militaire pasteurien travaillant sur le terrain, et tels qu’ils m’ont été énoncés par un médecin-général de Bordeaux ayant travaillé toute sa vie en Asie, sont les suivants :
- Médecine mobile adaptée au terrain. Aller sur place, examiner chaque individu, qu’il soit apparemment sain où malade.
- Enquête épidémiologique initiale. Il faut évaluer le taux d’endémicité ; c’est l’une des tâches des unités mobiles. Cela signifie surveiller les épidémies existantes mais aussi le potentiel d’émergence de telle ou telle autre maladie.
- Etablir les priorités d’interventions rapides contre les épidémies les plus mortelles. Prophylaxie de létalité suivie de prophylaxie spécifique.
- Choisir les moyens d’intervention. Ils doivent être efficaces, mais rapides.
- Mener le combat avec un service spécialisé sans frontières rigides, muni d’une direction centralisée et de personnel spécialement qualifié.
- Le combat doit être coordonné par un médecin. Etant donné que la maladie est « vivante », mouvante et changeante, l’épidémiologie bien comprise tient de l’art de la guerre, ce que le Colonel Jamot avait parfaitement compris.
Evénements historiques et scientifiques
1822 : -Naissance de Louis Pasteur
1848 : -Révolution, fin de la Monarchie de juillet, Louis Napoléon Bonaparte élu Président.
-Découverte de Pasteur sur la polarisation rotatoire.
1851 : -Louis Napoléon restaure l’empire.
-Bilharz découvre le parasite de ce qu’on appellera la Bilharziose.
1854 : -Naissance de Paul Ehrlich.
1857 : -Pasteur : Mémoire sur la fermentation.
1860 : -Pasteur : Mémoire sur la dissymétrie moléculaire des produits organiques naturels.
1861 : -Pasteur reçoit la visite du colonel Favé, aide de camp de Napoléon III.
1863 : -Naissance d’Albert Calmette.
1864 : -Pasteur : Etudes sur la « Maladie du vin ».
1870 : -Guerre Franco-allemande. Chute de l’Empire, début de la Troisième République.
1871 : -Armauer Hansen trouve le bacille de la lèpre (Hansen Bacillus).
1876 : -Pasteur : candidat aux élections sénatoriales, sur le slogan « Science et Patrie ».
-Bankroft trouve la forme adulte de la microfilaire qui produit l’Eléphantiasis.
1878 : -P. Manson démontre que la filaire de Bankroft (qui est l’agent de l’Eléphantiasis) est transmise par les moustiques.
1880 : -Pasteur découvre le staphylocoque et le streptocoque.
-Pasteur expose les principes des virus vaccins.
-Travail sur le choléra des poules.
-Alphonse Laveran démontre qu’un hématozoaire est à l’origine du paludisme, à l’hôpital de Constantine, Algérie.
1881 : -Carlos Finley de Cuba apporte la première preuve dans l’histoire d’une maladie transmise par un moustique : la fièvre jaune transmise par le moustique Stégomyie.
1882 : -Metchnikoff découvre la phagocytose à Messine.
1883 : -Pasteur envoie une mission sur le choléra en Egypte. Thuillier en meurt. Mission rapatriée.
-Robert Koch (Allemand) trouve le bacille du choléra (Koch bacillus).
-Klebs (Allemand) découvre le bacille de la diphtérie, puis Loeffler le cultive. (Bacille de Klebs-Loeffler)
1885 : -Pasteur : première vaccination antirabique sur l’homme.
1886 : -Création d’un Institut Pasteur à St Petersburg (Russie).
1887 : -Le Président de la République Sadi Carnot signe le décret pour l’établissement de l’Institut Pasteur.
1888 : -Inauguration de l’Institut Pasteur à Paris.
-Sadi Carnot crée le « Corps de Santé Colonial ».
-Création de l’Ecole de Santé Navale de Bordeaux.
-Calmette va à Saigon pour y créer le premier Institut Pasteur d’outremer.
1893 : -Pasteur envoie son neveu, le Dr A.Loir à Tunis.
-Maurice Nicolle crée l’Institut de Bactériologie Ottoman à Constantinople (maintenant Istanbul).
-Emile Roux et Alexandre Yersin identifient la toxine du bacille diphtérique, et découvrent la sérothérapie.
-Metchnikoff se joint au nouvel Institut Pasteur.
1894 : -Yersin trouve le bacille de la peste à Hong Kong (Yersinii pestii)
-Assassinat de Sadi Carnot.
1895 : -Pasteur meurt le 28 Septembre. Emile Duclaux devient directeur de l’Institut Pasteur.
-Yersin crée l’Institut Pasteur à Na Trang (Indochine)
1896 : -Paul Doumer nommé Gouverneur général de l’Indochine. Il y restera 6 ans, protège Yersin.
-Marchoux crée le premier laboratoire pasteurien à St Louis du Sénégal.
-Laboratoire fondé à Tananarive (Madagascar).
1898 : -P.L. Simond de l’I.P. démontre le rôle de la puce dans la transmission de la peste du rat à l’homme, à Bombay.
-Ross (Anglais), puis Grassi (Italien), informés par Manson et Laveran, démontrent le rôle du moustique l’Anophèle dans la transmission du paludisme.
1899 : -Albert Calmette fonde l’Institut Pasteur de Lille.
1900 : -Exposition Universelle. Eiffel complète sa « Tour Eiffel ». Les Pasteuriens, dont Jamot, participent à la grande exposition coloniale.
-Inauguration de l’Hôpital Pasteur, construit selon les principes de Roux pour l’isolation parfaite des personnes atteintes de maladies infectieuses.
1901 : -Mission de l’I.P. au Brésil : Marchoux, Simond, Salimberi pour étudier la fièvre jaune, (jusqu’en 1905).
1902 : -Forbes et Joseph Dutton (Anglais) découvrent le trypanosome (agent de la maladie du sommeil) sur un patient de la Gambie (Trypanosoma Gambiense).
-Doumer et Yersin créent l’Ecole de médecine de Hanoï.
1903 : -Donovan (Anglais) découvre l’agent de la leishmaniose (Leishmania Donovani).
-Castellani identifie définitivement le rôle du Trypanosoma Gambiense, retrouvé dans le liquide céphalo-rachidien d’un malade de l’Ouganda, atteint de la maladie du sommeil ou trypanosomiase.
-Découverte du rôle de la glossine, vulgairement appelée mouche tsé-tsé dans la reproduction du trypanosome, et la transmission de la maladie (rôle dans l’étiologie de la maladie)
1904 : -Calmette fonde « La Ligue du Nord contre la Tuberculose ».
-Mort de Duclaux, Emile Roux prend la direction de l’I.P.
-Jules Bordet (fondateur de l’immunologie avec Metchnikoff) fonde l’Institut Pasteur du Brabant en Belgique.
1905 : -Découverte du premier médicament contre les trypanosomes : l’Atoxil.
-Mission de l’IP : Gustave Martin, mission d’étude sur la maladie du sommeil en Guinée.
1906 : -Marchoux établit l’Institut Pasteur de Bamako (Mali) qui, se spécialisant sur la lèpre par la suite, deviendra l’Institut Marchoux, pour honorer l’homme qui dévoua sa vie à la recherche sur cette maladie.
-Mission de l’IP sur la maladie du sommeil. Thiroux au Sénégal, Bouffard dans la région de la boucle du Niger, Martin, Lebœuf et Roubaud au Congo français, Bouët en Côte d’Ivoire et au Nord du Dahomey.
1908 : -Charles Nicolle découvre le toxoplasme Gundii (dont on reparle aujourd’hui puisque c’est l’agent de la toxoplasmose, maladie dite « opportuniste » associée au SIDA).
-Laveran et Mesnil créent la « Société de Pathologie Exotique ».
-Création de l’Institut Pasteur de Brazzaville (Congo), par Martin, de l’Institut Pasteur de Tanger (Maroc) par Remlinger et de l’Institut Pasteur d’Abidjan (Côte d’Ivoire).
1909 : -Charles Nicolle découvre le rôle du pou dans la transmission du typhus exanthématique, première démonstration dans l’histoire du mécanisme de « transmission indirecte » d’une maladie (l’homme se gratte après la piqûre du pou et s’inocule l’agent pathogène).
-Chagas découvre la trypanosomiase du Brésil. Oswaldo Cruz identifie le parasite (Trypanosoma Cruzi). Par la suite, cette trypanosomiase est appelée la « Maladie de Chagas ».
1910 : -Levaditi découvre le virus filtrable à l’origine de la poliomyélite.
-Stephens fantham (Anglais) découvre un nouveau type de trypanosome sur un malade de Rhodésie (Trypanosoma rhodésienne).
-D’Herelle, au Mexique, découvre le bactériophage lors de ses recherches sur les bactéries qui pourraient être utilisées contre les sauterelles, qui ont alors envahi le pays.
-Edmond Sergent crée l’Institut Pasteur d’Alger (premiers fondements en 1894).
1913 : -fondation de l’Institut Pasteur de Nouméa (Nouvelle Calédonie)
1914 : -Jean Jaurès est assassiné. Première guerre mondiale.
-Eugène Jamot participe aux opérations qui chassent les Allemands du Cameroun.
-L’institut Pasteur de Paris est mobilisé et participe à l’effort de guerre (gaz, guerre chimique ...)
1916 : -Jamot est nommé Directeur de l’Institut Pasteur de Brazzaville.
1917 : -Arrêté du Gouverneur de l’Afrique équatoriale française (AEF) chargeant Jamot de créer l’organisation des Services spéciaux de la maladie du sommeil en Oubangui-Chari.
1920 : -Etude de Jamot sur l’élevage bovin au Cameroun.
-Une Commission de la Société de pathologie exotique établit la carte de la maladie du sommeil (Lebœuf, Martin et Roubaud sont les auteurs).
-Calmette crée un Institut Pasteur à Athènes.
1921 : -Institut Pasteur de Téhéran, Iran.
1922 : -Jamot lance la lutte contre la maladie du sommeil au Cameroun.
-Mort de Laveran.
1924 : -Calmette et Guérin trouvent un vaccin contre la tuberculose : un bacille atténué (pendant 20 ans, par passage sur 256 bovins), le BCG (Bacille Calmette-Guérin).
-Calmette crée un centre d’élevage de singe, « Pastoria » pour les besoins de la recherche, à Kindia, en Guinée-Conakry.
-Institut Pasteur de Dakar, (Sénégal) créé par Marchoux, Calmette et Mesnil.
1925 à 1936 : Construction du chemin de fer Congo / Océan, long de 512 km, grand déplacement de population avec contrôle épidémiologique insuffisant : 30 % des travailleurs meurent tous les ans ! Par contre le chemin de fer du Mossi, Ouagadougou-Bobo-Dioulasso, mieux conçu, n’entraînera aucune mortalité.
1925 : -Noël Bernard crée l’Institut Pasteur de Hanoi
1926 : -Mission Jamot : Mission permanente de la maladie du sommeil.
1931 : -Paul Doumer est élu Président de la République.
-Novembre : Jamot interdit de séjour en AEF.
1932 : -Jamot est réhabilité, va à Ouagadougou, crée l’Ecole d’infirmiers spécialisés (dans le dépistage de la maladie du sommeil).
-Paul Doumer est assassiné par le Russe Gorgukov.
1934 : -Jamot dépiste 38 000 trypanosomés (c’est-à-dire malades) en Afrique occidentale française (AOF).
1935 : -Rapport final de Jamot.
-L’Académie des sciences coloniale demande la création d’un service général autonome de la maladie du sommeil (SGAMS) sur la base du rapport Jamot.
1938 : -Institut Pasteur de Shanghai créé par Raynal.
1939 : -Création du SGAMS en AOF et au Togo, par décision de Mandel, ministre des Colonies. Gaston Muraz, émule de Jamot, nommé directeur.
1944 : -Conférence de Brazzaville, discours de De Gaulle sur l’indépendance des colonies venues à maturité politique.
-A cette même conférence Marcel Vaucel propose d’étendre le système Jamot d’équipes mobiles à toutes les autres grandes endémies : lèpre, paludisme, onchocercose, affections oculaires, tréponématose, méningite cérébro-spinale, ainsi que les vaccinations en zones rurales.
1948 : -Institut Pasteur de Guadeloupe.
1953 : -Paul Richet applique à la lèpre les principes de Jamot et dirige le Service général d’hygiène mobile et de prophylaxie, le SGHMP, qui a pris la place du SGAMS en 1945.
1959 : -Institut Pasteur de Yaoundé (Cameroun), qui s’appelait auparavant le Centre médical de Yaoundé.
1960 : -Richet crée l’Organisme de coordination et de coopération pour la lutte contre les grandes endémies (OCCGE).
1961 : -Institut Pasteur de Bangui (Centre Afrique).
1963 : -Création de l’Organisme de coordination pour la lutte contre les grandes endémies en Afrique centrale (OCEAC).
ANNEXE1 Médecine Tropicale - Projet d’action épidémiologique
Une proposition de la Commission médicale de la Fondation pour l’énergie de fusion
Ce projet d’action épidémiologique s’adresse aux responsables de la santé de tous les pays concernés, ainsi qu’aux spécialistes de prophylaxie pour les maladies tropicales, afin d’entamer un dialogue rapide quant aux actions à envisager et aux moyens à déployer face à une situation épidémiologique grave. Son but est aussi d’engager une réflexion, et une action, dans le domaine politique. Car qui dit action dit crédits et allocations en hommes et en matériels.
Il s’adresse aussi à tous les citoyens concernés.
Aucune maladie infectieuse n’a jamais été vaincue sans une amélioration des conditions économiques alliée à un déploiement épidémiologique de type militaire. La science de l’épidémiologie est l’art de combattre une maladie sous sa forme collective : endémique, ou épidémique, comme un « être vivant ». La maladie infectieuse évolue, subit des mutations, interagit sur d’autres maladies.
L’actuelle dégradation catastrophique de la situation sanitaire dans le monde, que l’on constate avec la pandémie de SIDA et la résurgence dans l’hémisphère sud de maladies infectieuses qui avaient été plus ou moins jugulées, est imputable à la fois à une détérioration sévère du niveau de vie des populations et à l’abandon des pratiques épidémiologiques mises au point par les disciples de Louis Pasteur.
Il y a quelques mois, le gouvernement tchadien annonçait qu’une épidémie de maladie du sommeil (trypanosomiase) affectait 10 000 personnes dans le sud du pays. Les services sanitaires ont installé des tentes pour soigner les sujets atteints. Si l’épidémie venait à s’étendre aux régions ou pays voisins, a déclaré N’Djamena, les services sanitaires seraient totalement débordés. Seule une aide de la communauté internationale permettrait alors d’enrayer la progression de l’épidémie.
La situation dans cette région de l’Afrique dénote l’effondrement des programmes de dépistage et de lutte contre les insectes. Elle traduit l’abandon du contrôle épidémiologique qui caractérise à l’heure actuelle l’ensemble de l’Afrique, de même que d’autres régions du secteur dit en voie de développement, comme l’Amérique latine et une grande partie de l’Asie du Sud.
Les responsables ne sont pas les gouvernements de ces pays, mais les nations industrialisées occidentales qui ne respectent pas, dans leur pratique politique et économique, les préceptes fondamentaux de la « loi naturelle ».
Le système de l’usure, qui n’a jamais eu que mépris pour la richesse la plus précieuse de notre civilisation, la vie humaine, engendrera des fléaux, disait Charles Nicolle.
Selon l’Organisation panaméricaine de la santé (OPS), 24 millions de personnes en Amérique latine souffrent de la maladie de Chagas, dont deux millions dans le seul Mexique (où 20 % du stock sanguin est contaminé), et 65 million sont menacées par cette maladie. (Le Trypanosoma Cruzi, responsable de la maladie de Chagas, provoque une pathologie différente du T. Gambiense et du T. Rhodesiense, responsables de la célèbre « maladie du sommeil » en Afrique.)
La trypanosomiase identifiée par le chercheur brésilien Chagas, d’où son nom de « maladie de Chagas », est essentiellement transmise par une espèce de punaises (les réduvidés), alors que la maladie du sommeil africaine est transmise « biologiquement » par la mouche tsé-tsé.
Ces deux formes de trypanosomiase ont ceci de commun qu’elles ne sont facilement guérissables que dans la phase initiale de l’infection, et qu’il n’y aurait pas de transmission possible sans la présence d’insectes.
Les chercheurs brésiliens viennent d’exprimer leur inquiétude quant à une forme plus virulente de Chagas qui pourrait naître chez des personnes HIV +, dans un pays très touché par le SIDA. En Afrique centrale, des médecins disent qu’en l’absence de tests, .il est parfois difficile dans les campagnes de distinguer le mourant du SIDA de celui de la maladie du sommeil : les deux sont cachexiques, les deux font une démence. L’Organisation mondiale de la santé (OMS) admet que les chiffres concernant les personnes touchées par la maladie du sommeil en Afrique sont largement en-deçà de la réalité, et que seules les éruptions occasionnelles particulièrement dramatiques sont rapportées. Il y a deux ans, par exemple, 20 000 cas ont été rapportés en Ouganda.
Le rapport de l’OMS en 1986 sur la trypanosomiase en Afrique fait état du danger qui existe à l’heure actuelle d’une épidémie incontrôlable qui pourrait affecter l’ensemble du continent, rappelant celles du début du siècle qui ont décimé la population de régions entières. [8]
Si nous continuons à ignorer le nombre des sujets atteints ou porteurs, et à ne pouvoir les localiser, nous allons nous trouver démunis devant une éventuelle et probable explosion soudaine de la maladie - une chose que Jamot, dans sa légendaire guerre contre la maladie du sommeil, avait bien comprise au début du siècle (voir chapitre V : De Calmette à Jamot).
Une situation semblable existe en ce qui concerne la lèpre, qui frappe durement l’Afrique centrale. Selon la revue Acta Leprologica, de l’Ordre de Malte, le nombre des lépreux double chaque année depuis cinq ans ; à la mi-1987, on estimait leur nombre à 11 millions. Le nombre des personnes contaminées augmenterait encore plus vite. L’Ordre de Malte attribue cette effrayante augmentation exponentielle à l’abandon du dépistage spécialisé dans les villages. Les médecins ou auxiliaires paramédicaux ne sont pas formés à la détection précoce de la maladie, ne serait-ce, par exemple, qu’en examinant la plante des pieds des villageois pour y déceler d’éventuels signes d’anesthésie indiquant une affection du système nerveux central. Non décelée, et par conséquent non traitée, la lèpre évolue en provoquant une défiguration, une mutilation irréversible des tissus et les dommages neurologiques que l’on connaît. Lorsqu’il reçoit des soins, le malade en est déjà à un stade où ses plaies purulentes ont contaminé d’autres personnes, soit par contact direct, soit par l’intermédiaire des mouches dont on pense qu’elles agissent comme vecteurs mécaniques. Il est nécessaire de dépister et de traiter la lèpre avant que la maladie n’arrive à son stade contagieux et mutilant, si l’on veut arrêter l’épidémie.
Dans cette même région du monde, le dépistage de la tuberculose a aussi pratiquement disparu. Comme la lèpre, la tuberculose est une maladie de la pauvreté, qui se développe dans des conditions de déficience immunitaire, et, à son tour, provoque une réaction d’autodestruction de l’immunité. Une corrélation très ’nette a été établie entre le SIDA et la tuberculose, cette dernière maladie étant devenue la première manifestation du SIDA chez 50 % des malades en Afrique centrale, en Guyane ’et en Haïti. Qui plus est, le mycobacterium de la tuberculose pourrait être un cofacteur prédisposant la personne à contracter l’infection à l’HIV [9]. Enfin, la tuberculose chez le sujet HIV+ est généralement intraitable.
Le paludisme effectue aussi, un retour en force, mondialement. On assiste aujourd’hui à la dissémination d’un type de plasmodium falciparum, l’hématozoaire responsable des formes pernicieuses de paludisme, résistant à la chimiothérapie. De surcroît, il apparaît aujourd’hui en Angola des formes de malaria cérébrale gravissimes, incurables, chez des personnes contaminées par le HIV.
La progression du paludisme va clairement de pair avec le recul des programmes de lutte contre les insectes. Les chiffres de l’OMS pour l’Amérique latine sont éloquents. Dans un rapport de 1987, Conditions sanitaires dans les Amériques, 1981-1984, cet organisme reportait les faits suivants : en 1959, on recensait au Mexique 3202 cas de paludisme et 6 560 183 fumigations, tandis qu’en 1984, les cas de paludisme s’élevaient à 85 501 et le nombre des fumigations étaient tombé à 338 538. Au Venezuela : 1210 cas en 1962, pour 540 069 fumigations ; 11 128 cas en 1984, pour 179 645 fumigations. En Colombie : 4172 cas en 1959 pour 2 357 627 fumigations ; 105 360 cas en 1983, pour 380 043 fumigations. Enfin au Brésil on est passé de 8297 cas de paludisme en 1960, à 378 257 cas en 1984, avec une légère augmentation des fumigations.
En l’absence de dépistage et de traitement, un nombre grandissant d’enfants souffrant du paludisme ne reçoivent des soins hospitaliers (lorsqu’ils en reçoivent !) que lorsqu’ils ont atteint un état d’anémie grave, nécessitant des transfusions de sang. On estime que ces dernières années, des centaines d’enfants ont ainsi reçu du sang contaminé par le virus HIV dans le seul hôpital Mama Yemo, à Kinshasa, les banques du sang ayant été contaminées dans toute l’Afrique, à l’exception de quelques instituts médicaux importants. Jusqu’à présent, les Etats-Unis et les organismes de secours internationaux ont été plus prompts à distribuer des préservatifs que des tests Elisa pour le dépistage du sang, ou même des seringues propres.
Le choléra est présent sur 80 % du continent africain, et une parasitose comme la bilharziose affecte encore plus de deux cents millions de personnes.
Et que dire du dépistage du SIDA ?
L’OMS, le Centre de contrôle des maladies (CDC) d’Atlanta, et les autorités médicales de tous les pays avancés en général s’opposent énergiquement à tout dépistage systématique de l’HIV let de l’HIV 2. Et ce sous le prétexte fallacieux qu’en l’absence de traitement, le dépistage ne pourrait que causer du tort à ceux qui s’avéreraient être porteurs du virus !
Rappelons ici que le pasteurien Jamot mena initialement la guerre épidémiologique à la maladie du sommeil en Afrique avant de pouvoir traiter efficacement les malades, alors qu’il ne disposait que d’un médicament, l’Atoxil, qui « blanchissait » les sujets atteints, c’est-à-dire tuait les trypanosomiases dans le sang de ces malades : ceux-ci ne guérissaient pas si le liquide céphalo-rachidien était contaminé, mais au moins ils n’étaient plus contagieux. Il est ainsi envisageable que demain nous ayons les moyens, par exemple, de limiter la virémie des sujets HIV +, bien avant de trouver un remède...
Le fondateur du premier laboratoire pasteurien en Afrique, A. Thiroux, n’hésita pas à créer un « village de ségrégation des sommeilleux » près de son laboratoire de Saint-Louis du Sénégal, afin d’isoler les malades des sujets bien portants pour réduire la contagion dans les villages et offrir les meilleurs soins possibles aux malades.
Rappelons encore l’exemple d’A.Calmette et de sa guerre à la tuberculose : le dépistage systématique, foyer par foyer, et sur tous les lieux de travail, les lois sanitaires et mesures prophylactiques pour arrêter l’épidémie furent ainsi prises vingt ans avant qu’il n’arrive à inventer le BCG, et une quarantaine d’année avant la découverte des antibiotiques.
Si nous continuons à nous aveugler de la sorte devant la progression rapide du SIDA et la résurgence concomitante d’autres maladies, nous serons totalement démunis dans un futur proche. L’argument en faveur du « laissez faire » recouvre en réalité une volonté d’organiser un véritable « triage » des « races de couleur », comme l’indiquent les appels à réduire la population africaine, tel celui lancé par le Conseil interaction de l’ancien chancelier ouest-allemand Helmut Schmidt, lors d’une réunion à Nairobi en mars dernier, ou la décision de la communauté financière de couper tous les crédits à ce continent, si ce n’est pour rembourser les dettes.
L’opposition farouche à toute idée de dépistage systématique des virus HIV dans le secteur dit en voie de développement s’explique avant tout par la volonté de dissimuler l’abandon du dépistage des autres maladies, les considérations étant essentiellement d’ordre budgétaire.
Le dépistage de l’ensemble de la population pour toutes les grandes maladies endémiques et épidémiques, s’accompagnant d’une évaluation de l’état immunologique de la population, serait de la première importance pour mieux comprendre le SIDA et pour en limiter les ravages. C’est aussi le seul moyen efficace pour juguler le développement des grandes épidémies pour lesquelles nous disposons de traitements.
Pour qu’un déploiement épidémiologique soit efficace, il est nécessaire de rassembler un certain nombre de renseignements stratégiques relatifs à la distribution géographique des principales maladies, à la virulence des différentes souches, aux conditions environnementales, aux interactions éventuelles entre maladies, et ainsi de suite.
Les frères Sergent, qui furent avec Charles Nicolle les pionniers des études épidémiologiques en Afrique du Nord, insistaient sur ce qu’ils appelaient le « seuil de danger » d’une maladie qui est défini par le nombre de porteurs asymptomatiques, le nombre de malades et le nombre d’insectes de différentes espèces dans une région donnée. Ils soulignaient qu’il était essentiel de comprendre l’existence de maladies endémiques et que l’endémicité évolue vers une épidémie sous une forme initialement « invisible », celle des porteurs asymptomatiques.
Chercher, trouver, traiter et isoler les porteurs, telle était à leurs yeux la responsabilité première de l’épidémiologiste. Alors qu’une prise de sang, et dans certains cas une ponction lombaire, suffisait à leur époque, il faut ajouter aujourd’hui des techniques plus perfectionnées :
- Prises de sang avec multiples examens physico-chimiques et biologiques, recherches d’anticorps, tests immunitaires, etc.
- Ponctions lombaires et analyses du liquide céphalo-rachidien, pour dépister notamment la tuberculose, la maladie du sommeil, et même l’infection HIV, puisqu’on sait déjà qu’il peut y avoir beaucoup plus d’HIV que dans le sang.
- Examens des selles, endoscopie et éventuellement biopsies, en fonction des cas, chez les sujets souffrant de diarrhées. [10]
- Electrocardiogrammes, pour détecter les désordres cardiaques, en particulier chez les sujets tuberculeux âgés, certains patients souffrant de la maladie de Chagas etc.
- Imagerie par résonance magnétique nucléaire (RMN), pour déceler les lésions cérébrales, même infimes, chez les patients atteints du SIDA. [11]
Un tel programme de mobilisation dans le style de la médecine militaire, sur des bases épidémiologiques déjà éprouvées avant la deuxième guerre mondiale, nous permettrait d’obtenir : 1) une carte de l’étendue des maladies virales, bactériennes et parasitaires, ainsi que de stopper leur propagation, par des traitements appropriés ou des vaccinations ; 2) une carte de l’état immunitaire des populations, de même qu’une première estimation de l’état neurologique de ces populations.
A l’heure actuelle, les manifestations neurologiques du HIV ne sont même pas admises dans la définition du SIDA qu’a adoptée l’OMS pour les Africains, la « définition de Bangui ».
Quelles mesures doivent être prises dans le domaine des équipements médicaux, sanitaires et hospitaliers, de la formation, des infrastructures, pour que puisse être mis en œuvre le plus rapidement possible un programme de dépistage épidémiologique général ?
L’action de l’Organisation de coordination pour la lutte contre les endémies en Afrique centrale (OCEAC), qui estimait en 1986 que seuls 30 % des sujets atteints de la tuberculose en Afrique étaient recensés, est exemplaire à cet égard. En 1983, cet organisme décidait de développer un réseau unique de laboratoires de base pour dépister à la fois la tuberculose et la lèpre.
L’OCEAC décidait, dans un premier temps de recenser rapidement l’équipement nécessaire aux bacilloscopies disponibles dans les laboratoires au niveau de tout un pays, l’équipement des laboratoires appelés à devenir des centres au niveau des régions et provinces, et tout l’équipement disponible dans les laboratoires. L’OCEAC décidait également de créer de nouveaux centres de dépistage. Dans un deuxième temps, l’objectif était d’obtenir quatre indicateurs sanitaires dans chaque province : le nombre de microscopes, celui des auxiliaires médicaux capables de dépister la lèpre et la tuberculose, et celui des bacilloscopies effectuées, par 100 000 habitants ; et enfin, le nombre de bacilloscopies par membre du personnel médical (une façon de vérifier leur compétence et leur sérieux.)
Cette étude concluait que l’équipement disponible était vastement sous-utilisé. On recensait 85 bacilloscopies par an et par agent (variations entre 20 et 185) ; 56 % des laboratoires manquaient de petit équipement en général (lames, réactifs, etc.). Les microscopes n’étaient pas entretenus ni réparés. On constatait une diminution des qualifications techniques du personnel.
Les principales décisions prises furent les suivantes : améliorations des fournitures aux laboratoires, un problème parfois financier mais le plus souvent logistique ; formation du personnel au dépistage de la lèpre et de la tuberculose, aux techniques de laboratoire et à une connaissance théorique ; rééquipement des laboratoires existants. Le Cameroun, par exemple, avait besoin de 10 microscopes pour en .avoir 1 par 100 000 habitants. Le prix moyen d’un microscope est environ de 5000 FF.
Cette analyse très utile appelle deux remarques essentielles. Tout d’abord, la réalisation du programme proposé par l’OCEAC doit être accélérée, ce qui n’est pas une mince affaire si l’on pense à la rapidité avec laquelle d’anciennes maladies se propagent à nouveau aujourd’hui, ou au fait que la plupart des médecins et du personnel médical africains ne disposent pas encore de seringues propres ni de désinfectant pour combattre l’épidémie de SIDA. Ensuite, le développement rapide de cette dernière épidémie en Afrique centrale fait que ce programme est déjà périmé, car il faut dépister aussi le SIDA.
La médecine spécialisée doit être réinstaurée en Afrique si nous voulons livrer cette nouvelle guerre scientifiquement. Depuis quelques années, l’OMS avance l’idée saugrenue, qui prêterait à rire si elle n’était aussi criminelle, de la « médecine aux pieds nus ». Comme le déclarait un ministre africain l’automne dernier, cette « médecine » consiste à enseigner l’usage du savon et de l’hygiène dans les villages. Et ce alors que l’eau est polluée !
Ce sont des brigades mobiles de personnel entraîné à des tâches spécifiques de dépistage et de traitement, sous la direction de médecins spécialisés, qu’il faut plutôt déployer.
Nous pouvons envisager un programme comportant trois niveaux :
- Un programme de type OCEAC accéléré, afin d’améliorer l’équipement des laboratoires existants et d’en créer de nouveaux.
- Le développement, le rééquipement et la construction d’hôpitaux en Afrique, les dotant notamment de machines à imagerie par RMN et d’équipements spectroscopiques, nécessaires non seulement à des fins cliniques, mais pour favoriser la création de centres de recherche fondamentale sur ce continent.
- La mise en place d’une médecine mobile de type Jamot, équipée de laboratoires mobiles sophistiqués, pour une efficacité maximale du contrôle épidémiologique, du traitement de masse, des vaccinations, etc. Les équipements de l’armée française, comme ceux qui sont utilisés par la Bioforce, qui comprennent notamment des avions faisant fonction de laboratoires-hôpitaux mobiles, donnent déjà une idée du matériel requis. [12] Nous devrions utiliser les possibilités qu’offrent les programmes spatiaux américain et européen, et concevoir un engin mobile de type « lunaire » pouvant être adapté à différents terrains, dans lequel serait transporté l’équipement nécessaire à tous les dépistages, examens et vaccinations.
Pasteur disait que la grandeur d’une nation lui vient de la qualité de ses savants. De la même manière, c’est à la qualité de ses pratiques sanitaires que l’on mesure si une nation promet de contribuer à améliorer le sort de l’humanité, ou, au contraire, si cette nation est sur la voie de la désintégration.
Affirmer, comme le font la Croix Rouge norvégienne et l’Institut PANOS, que c’est avec le « planning familial » que l’on va le mieux combattre le Sida en Afrique (par l’« éducation sexuelle » et les préservatifs), est pire qu’une insulte aux populations africaines, c’est une recommandation fondamentalement perverse, et la résistance de ces populations à cette « éducation sexuelle » est compréhensible.
Tout pays doit avoir pour dessein national d’accroître sa richesse en hommes, d’accroître à la fois le nombre de ses habitants et les facultés créatrices de chacun.
Le temps presse face aux dangers. Ou bien nous serons capables de lancer une renaissance dans le domaine de l’épidémiologie, ou bien nous sombrerons dans l’hystérie collective qui a souvent accompagné les grandes épidémies du passé comme la Peste noire.
ANNEXE 2 Vaincre le SIDA - Mesures d’urgences contre le SIDA proposées par la Commission médicale de la FEF
Nous devons, et nous devons de toute urgence, mettre en œuvre une véritable politique de santé publique. Les mesures que nous préconisons ci-dessous ne sont donc pas un simple catalogue de bonnes intentions, mais définissent, en se conjuguant, une stratégie globale et cohérente de mobilisation immédiate contre la maladie.
Trois raisons font que nous présentons ces mesures sous une forme résumée :
- Les réactions auxquelles nous assistons, bien que parfois individuellement excellentes, ne s’adressent au mieux qu’à une partie du problème, et donc sont insuffisantes et égarent l’opinion en fixant son attention sur un point particulier au détriment de l’ensemble.
- Les notions de « santé publique » et de combat anti-épidémiologique sont aujourd’hui largement ignorées ou incomprises, notamment dans leurs dimensions immunitaires, économiques et sociales qui dépassent la guérison individuelle des patients.
- Le regroupement des « points d’intervention » sous une forme synthétique favorise la compréhension de chacun en le plaçant par rapport à l’ensemble.
I Recherche
Création d’un Institut de Recherche Biologique contre le SIDA pluridisciplinaire, qui associe recherche fondamentale et expérience clinique sur le terrain.
Il s’agit de regrouper des spécialistes pour toutes les disciplines traditionnelles : virologie, biologie moléculaire, immunologie, neurologie, médecine tropicale, avec les meilleurs spécialistes dans le domaine de la recherche spectroscopique.
L’étude portera notamment sur la mesure des champs magnétiques des tissus vivants dans l’ensemble du spectre depuis les ondes radios jusqu’aux ultraviolets (y compris l’émission phototonique ultra faible). Le but est d’effectuer des analyses et des recherches sur les phénomènes électromagnétiques en biologie, dont Louis Pasteur fut le premier à souligner l’importance.
Des mathématiciens rompus aux méthodes riemanniennes devront aussi être associés à cet effort, afin d’assurer l’interprétation des données spectroscopiques.
Constitution, à la tête de l’Institut, d’un état-major scientifique, définissant les progressions de la stratégie de guerre au SIDA sans obstacles bureaucratiques, et doté de toutes les ressources en fonds publics et en personnel qu’il juge nécessaire à l’obtention rapide de percées scientifiques. Mise à la disposition de l’Institut de ses propres installations de recherche (laboratoires, équipements technologiques les plus performants, etc.). Organisation de l’enseignement et de séminaires à partir de l’Institut.
II Dépistage
Organisation d’un dépistage systématique, obligatoire et gratuit pour mesurer l’ampleur et la portée du fléau. Il doit être général afin de ne pas être discriminatoire et, sans nourrir l’illusion qu’il permettra de tout savoir à tout moment, il est le seul instrument à partir duquel peut être élaboré ce qui, au départ de toute démarche de santé publique, est indispensable : une cartographie de la maladie, et de la façon dont elle se propage.
III Information
Organisation d’une campagne d’information de masse à l’échelle nationale et régionale, mettant l’accent sur les principales caractéristiques connues de la maladie et tout particulièrement sur sa contagiosité.
La population sera tenue systématiquement informée des progrès effectués dans la connaissance et le traitement de la maladie, notamment au sein de l’Institut National de Recherche, et des conséquences à en tirer en matière d’hygiène et de santé publiques.
IV Qualité des soins
Dans l’attente de la découverte de remèdes permettant de guérir, les meilleurs soins existants doivent être constamment assurés aux patients :
- Pour soigner tant que possible les SIDA avérés, mise en place de services spécialisés de traitement dans chaque hôpital, bénéficiant d’une formation sérieuse au départ, et ensuite, informés au jour le jour des progrès de la science.
- Création d’hôpitaux modernes associés au nouvel institut de recherche et assurant le confort maximal des patients,
- Suivi médical régulier des « séropositifs » dans les centres spécialisés afin de faire tous les examens nécessaires, notamment neurologiques, pour aider le malade, et améliorer notre connaissance de l’évolution de la maladie.
L’objectif primordial est de prolonger autant que faire se peut la durée de vie des malades, en les assistant dès leur phase initiale, jusqu’au moment où les moyens de guérison seront découverts.
V Isolement et contagiosite
Ce domaine a fait l’objet de trop nombreuses polémiques, inspirées par des arrière-pensées démagogiques. Il faut partir de trois notions classiques en épidémiologie, aujourd’hui malheureusement oubliées : déterminer les moments de contagiosité, en analyser les vecteurs, et ensuite établir les modes éventuels d’isolement en fonction, d’une part de la protection de la société, d’autre part de l’intérêt même du malade, afin d’assurer la plus longue période possible de survie, dans l’attente de médications efficaces.
A cet effet, certaines mesures s’avèrent aujourd’hui nécessaires :
- Une étude sur les voies de transmission de la maladie tenant compte de l’environnement : étude épidémiologique des conséquences de piqûres multiples d’insectes en milieu tropical, étude sur la transmission rapide et la transmission lente en fonction du temps, du nombre et de l’intensité des contacts.
Tous les spécialistes de médecine tropicale sont d’accord sur un point aujourd’hui : la présence de maladies sexuellement transmissibles, de maladies de la peau, de toute lésion de la peau et des muqueuses, favorise la transmission du SIDA, comme pour toute autre maladie contagieuse. Le statut immunitaire, le statut alimentaire, le niveau de vie et d’hygiène des populations concernées détermineront donc dans une large mesure notre capacité à arrêter la progression (100 millions de HIV+ en 1990) de cette maladie. - L’isolement relatif des malades atteints de « SIDA avéré », soit à l’hôpital, soit dans des centres de traitement spécialisé, soit au domicile, ceci dans l’intérêt de la population et dans leur propre intérêt, pour éviter leur exposition constante à des « maladies opportunistes ».
- Des interdictions professionnelles, y compris pour les « séropositifs » contagieux, lorsque les professions impliquent un danger de contamination (secteurs de santé publique : médecins, infirmiers, dentistes ; secteurs alimentaires : cuisiniers, serveurs ; secteurs de l’éducation). Il est bien entendu établi que ces interdictions ne pourront en aucun cas impliquer un « blocage » de carrière, et qu’elles seront réexaminées au fur et à mesure des progrès accomplis dans la connaissance de la contagiosité et dans les traitements médicaux. Un emploi de niveau comparable à celui précédemment occupé devra être garanti, dans des secteurs qui ne soient pas « à risque ».
Cette politique n’est pas nouvelle ; elle s’inspire du combat mené dans le passé contre les autres grandes maladies contagieuses (tuberculose, lèpre, syphilis ...) lorsque n’existaient pas de remèdes ou de moyens de neutraliser la maladie.
Elle est cohérente en tout point similaire à celle Instituée par Calmette quand il fonda la « Ligue du Nord Contre la Tuberculose » en 1904 : dépistage dans les foyers et sur les lieux de travail, loi sur l’isolement relatif, loi sur les interdits professionnels, lois d’hygiène générale pour le commerce et l’alimentation, aide financière aux malades et à leur famille, vingt ans avant que Calmette ne trouve le BCG.
VI - Aide aux pays du tiers-monde affectés
La qualité de notre engagement dans la lutte contre la maladie nous fait un devoir d’assistance en faveur des pays moins bien pourvus et plus affectés. Ce devoir sera d’autant plus efficace que sur le sol français, en Guyane, en Martinique et en Guadeloupe, nous avons l’expérience de conditions épidémiologiques assez proches des conditions dont souffrent les pays du tiers monde tropical.
Nous proposons donc :
- La mise en place d’un programme en faveur de l’Afrique autour d’un Centre africain adjoint à l’Institut de recherche biologique.
- Une aide importante pour renforcer et remettre sur pied un service de prophylaxie compétent qui comprenne des équipes mobiles de dépistage et de traitement capables de couvrir l’ensemble de la population en Afrique (et dans les autres pays du tiers monde), afin de combattre l’ensemble des épidémies d’une part, et d’établir une évaluation compétente de l’étendue du SIDA d’autre part.
- La livraison de tests de dépistage, et d’équipements de laboratoire, de telle sorte que le dépistage puisse se faire partout.
- L’aide financière et matérielle pour la construction d’hôpitaux, et l’équipement en laboratoires d’analyse des hôpitaux existants quand ils en sont encore dépourvus, surtout dans les campagnes.
- Dans l’immédiat, la livraison massive de seringues jetables pour éviter que la transmission par seringues continue à être un vecteur privilégié de la maladie.
- Et aussi, dans l’immédiat, l’aide à l’assainissement de l’environnement (évacuation des eaux, amélioration de l’habitat, fumigations et recherche sur les moyens modernes, notamment électromagnétiques, qui pourraient être mise en œuvre contre les insectes.)
En conclusion, ce programme complet de santé publique n’est pas un luxe de précautions plus ou moins inutiles, mais un tout cohérent qui vise à relever un défi, un défi de vie ou de mort.
Il se base d’une part sur une mobilisation en profondeur de notre appareil de recherche avec un objectif absolu : guérir le SIDA ; et d’autre part sur l’application aux cas de SIDA de dispositions existantes dans le cas d’autres maladies contagieuses.
L’épidémie de SIDA qui affecte le monde est un défi politique autant que technique ; il ne peut donc être relevé par les seules autorités médicales. La maladie résulte en effet d’un effondrement des conditions de vie, d’environnement et d’hygiène dans certaines parties du monde ; y faire face consiste à rétablir une politique de santé publique digne de ce nom.
Il permettra en outre de jeter dans ce domaine les bases d’une grande politique française d’assistance aux pays du tiers monde atteints, en particulier sur le continent africain.
L’investissement financier à réaliser sera, en tout état de cause, largement « remboursé » par les découvertes fondamentales effectuées dans les sciences de la vie, par la sauvegarde de millions de vies humaines et par la création de conditions nouvelles de progrès dans les pays du Sud propres à relancer une croissance mutuelle.